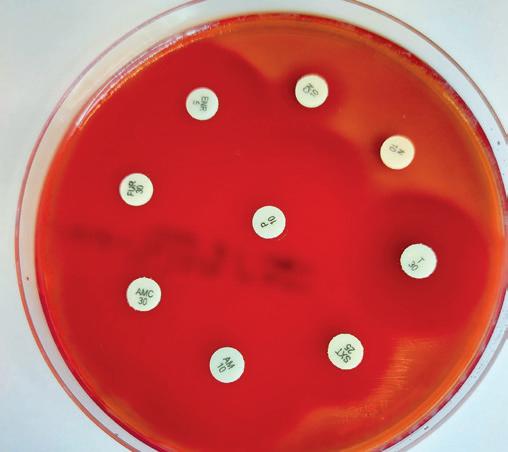

Remembering the great Virginia-Bred SECRETARIAT on the 50th anniversary of his Triple Crown!







Wishing Virginia-Raised FORTE and his connections the best of luck in The Kentucky Derby


















Remembering the great Virginia-Bred SECRETARIAT on the 50th anniversary of his Triple Crown!







Wishing Virginia-Raised FORTE and his connections the best of luck in The Kentucky Derby





In this our Triple Crown issue, we profile two trainers who are very much focused on building their businesses around their home states, and neither are tempted or inclined to run multistate stables.
Our cover profile trainer, Brittany Russell recently enjoyed her first Gr.1 success in the Carter Handicap at Aqueduct with Doppelganger; and in the three years since saddling her first runner, she has made quite an impression on the mid-Atlantic circuit—specifically in Maryland where she and her jockey husband, Sheldon, call home.
“I’m not looking past Maryland. Most of my business is built around Maryland. I have a full barn because we’re winning here and doing well here. People are sending me horses that fit here. You want to be bigger and better, go to bigger racetracks and win bigger races. Obviously, those are goals. But for the time being, I’m just trying to stay very grounded. I’m trying to do well where I am right now.”
As Ken Snyder discovers, there is a huge amount of mutual respect between Russell and one of her previous employers, Brad Cox.
“If I hadn’t gone out on my own, I hope I’d still be there. He did a good job. He was so good to work for,” says Russell.
Cox credits Russell for a major move in his career—the New York circuit. “Having her gave me the confidence, I would say, to go there. She played a big role with us getting our foot in the door in New York and obviously, staying there. She was the one that really kind of got things going for me in New York.”
Ben Colebrook is the subject of our second trainer profile and like Russell, is very much focused on keeping his business close to home. For Colebrook, home is Kentucky and as he recently told Frances J. Karon, Keeneland has been pivotal to his success as a trainer.

“Keeneland’s part of the reason why I’ve had, if you can call it a successful career, it’s been because of being stabled at Keeneland. It’s probably the major reason why I’ve gotten horses. People want to have their horses here, and there’s only so many stalls down there on Rice Road.”
Colebrook trained his first Gr.1 winner back in 2018 when Knicks Go won the Claiborne Breeders’ Futurity at his home track. But this year, Colebrook is very much looking forward to the Triple Crown series of races with his recent Gr.3 Gotham Stakes victor, Raise Cain, set to become Colebrook’s first runner in a Classic race. Both Russell and Colebrook are already having quite a year to remember.
Wherever racing takes you during the Triple Crown seasongood luck!
Last September, we witnessed the unprecedented energy, magic and momentum of the most successful September Yearling Sale in history. And this year, when the World’s Yearling Sale returns – when the eyes of the Thoroughbred industry descend once more upon Keeneland It All Begins Again.
The record-smashing results of the September Yearling Sale Sale begins Sept. 11

Editorial Director/Publisher & Advertising Sales


Giles Anderson (859) 242-5025
Sub-Editor
Jana Cavalier
Advert Production, Circulation/Website
Lauren Godfray (1 888-218-4430)
Cover Photograph
Scott Serio/Eclipse Sportswire
Trainer Magazine is published by Anderson & Co Publishing Ltd.
Tel: 1 888-218-4430 Fax: 1 888-218-4206 info@trainermagazine.com www.trainermagazine.com

North America
PO Box 13248, Lexington, KY 40583-3248
United Kingdom
Ground Floor Office, 72 Medstead Road, Beech, Hampshire, GU34 4AE
Alan F. Balch was hired as the executive director of the California Thoroughbred Trainers in April 2010. His professional career in racing began at Santa Anita in 1971, where he advanced to the position of senior vice president of marketing and assistant general manager, and was in charge of the Olympic Games Equestrian Events in Los Angeles in 1984. He retired in the early 90s to become volunteer president of the National Equestrian Federation of the USA, as well as of the National Horse Show of Madison Square Garden. He remains president of USA Equestrian Trust, Inc.

Alan Creighton specializes in biosecurity and the diagnosis and eradication of disease in equine premises. He advises on ventilation, layout, design and environmental aspects of equine premises. He has consulted on numerous new and rebuilds of racing yards throughout Europe. He is widely experienced in the UK, Ireland, Europe and the USA and is a respected lecturer and speaker on performance, biosecurity and environmental pathogens in the equine industry.
Bill Heller is an Eclipse Award-winning author, whose latest book is Fred Hooper – The Extraordinary Life of a Thoroughbred Legend. His other biographies include Hall of Fame jockeys Ron Turcotte, Randy Romero and José Santos. Bill and his wife Marianne live near Gulfstream Park. Bill’s son Benjamin is an accomplished marathon runner in New York.
Adam Jackson, MRCVS is a partner at Dunsford & Jackson, a modern independent equine vets group based in the South Downs National Park, serving West Sussex, Hampshire and Surrey. Initially, he started work in a mixed practice in Hampshire but because of his strong affinity towards horses, he began to focus on equine veterinary medicine and surgery. In 2004, he became an equine ambulatory veterinary surgeon and later completed his Master’s Degree at the Royal Dick, studying the epidemiology of notifiable equine infectious diseases. He was soon involved with care and treatment of horses that attended both the Rio and Tokyo Olympic and Paralympic Games.
Frances J. Karon is from Puerto Rico and a graduate of Colby College. She's based in Lexington, Kentucky, where in addition to her writing and photography, she is a pedigree advisor and bloodstock editor for Werk Thoroughbred Consultants.
Trainer Magazine is the official magazine of the California Thoroughbred Trainers. It is distributed to all ‘Trainer’ members of the Thoroughbred Horsemen’s Association and all members of the Consignors and Commercial Breeders Association, the Maryland Horse Breeders Association, the Pennsylvania Horse Breeders Association, the Alberta Thoroughbred Owners & Breeders Association and the Virginia Thoroughbred Association.

Kerrie Kavanagh is a PhD candidate (through the University Of Limerick) where her research focuses on studying the equine microbiome and developing an equine autogenous probiotic. Her work as a senior microbiologist at the Irish Equine Centre involves running the microbiology lab dealing with outbreaks such as strangles, reproductive venereal pathogens, enteric investigations, parasitology, epidemiology, water & environmental monitoring & disinfectant efficacy trials for equine use.
Ken Snyder is a current turf writer for Gallop magazine, and a turf/travel-culture writer for Kentucky Monthly magazine. His work has also appeared in other publications, including The Blood-Horse He and his wife, Cassie, reside in Kuttawa, Kentucky.
Trainer
Road, Jefferson City, MO 65101. Periodicals postage paid at Jefferson City, MO, and additional mailing offices.
POSTMASTER: Send address changes to Trainer Magazine, Anderson & Co Publishing, PO Box 13248, Lexington, KY 40583-3248.
EARLY RACEHORSE NOMINATION DEADLINE IS JULY 15, 2023. Runner not nominated? Deep discounts of nomination fees if done on or before July 15! All horses must be nominated to compete in the Breeders’ Cup World Championships offering over $31 million in purses and awards.
TWILIGHT GLEAMING (IRE) , Winner of the 2021 Breeders’ Cup Juvenile Turf Sprint Nominated for $12,000 as an Early Horse of Racing Age before becoming the 2021 $1 million Breeders’ Cup Juvenile Turf Sprint Champion.
RACING@BREEDERSCUP.COM

10 Brittany Russell – on track for a big year
Ken Snyder profiles Brittany Russell, fresh from saddling her first Gr.1 stakes winner with Doppelganger in the Carter Handicap at Aqueduct.

Frances J. Karon meets Ben Colebrook, who has been a “mainstay” trainer on the Kentucky circuit for the last decade. This year he’s looking forward to saddling his first starter in a Triple Crown race.
Adam Jackson, MRCVS explains, from a veterinary perspective why bucked shins are so prevalent in the racehorse and updates us on new rulings.



Kerrie Kavanagh talks about the use of probiotics as an alternative to antibiotics to reduce resistance in the gut.
The New York-bred program and Canadian Jockey Club both celebrate their 50th anniversaries this year. Bill Heller looks back at what they have achieved.


BioSecurity is crucial in minimizing infectious diseases and maximizing a horse’s health. Ken Snyder explores why it’s important to follow biosecurity protocols.

Bill Heller features Hunter Valley Farm, owners of A Mo Reay, John Ropes the owner of Dorth Vader and Andrew Warren, the owner of Raise Cain.
06 View from the CTT Alan Balch – The stress test!
Bill Heller asks “How closely do you follow veterinary advice if it conflicts with your gut feeling about your horse?”
Bill Heller explores the innovations to increase betting handle around the world. Visit trainermagazine.com to download our current digital editions and access back issues of both European and North American Trainer.



My old horse trainer, one of the wisest people I ever met— and I find many trainers to be so wise, way beyond their formal educations—used to define stress this way: the confusion created when one’s mind overrides the body’s basic desire to choke the living [bleep] out of some [bleep] who so desperately needs it.
Any trainer reading this will immediately recognize the sensation, surrounded as he or she is by countless other “experts” (at least in their own minds): regulators, do-gooders, gamblers, veterinarians, reporters, owners, blacksmiths, hotwalkers, entry clerks, and track officials—to name only a very few categories of her or his advisers.
Everyone else in racing these days (not to mention virtually everyone else on Earth) is experiencing that same sensation. Our mutual feelings of stress are ubiquitous— that is to say, they’re everywhere in virtually everything we’re doing.
I can remember a time, not that long ago, when people went to the races, or owned horses, to get away from politics. And stress. The objectivity of the photo-finish camera, invented nearly a century ago now, was a welcome relief from all the conflicting opinions outside the track enclosures. And my $2 was just as valuable as Mr. Vanderbilt’s.
To be certain, there have always been politics within racing—our own politics. And gradually, with politically appointed state regulators, non-racing politics, real politics, became more and more intrusive as the decades marched on.
What we have witnessed in the last few years, however, is something new. Or, perhaps, a throwback to the early 1900s, when much of American racing was simply abolished in the name of “reform,” which “reform” movement later led even to prohibition! It’s perhaps instructive that prohibition of alcoholic beverages ended about the same time that modern pari-mutuel betting on newly approved tracks began in the 1930s.
I’m not sure that what we’re witnessing now in racing—the advent of national, federal legislation to accompany and supplant state-by-state regulation—will be as cataclysmic for racing as what happened before in the name of “reform,” but I’m also not sure that it won’t be.
What it comes down to is this: how much reform did or does present-day racing really need? Are the Horseracing Integrity and Safety Authority (HISA) and its bureaucratic bedfellows actually going to result in whatever reform is really necessary? Or, are we going to fail this stress test?
The Jockey Club and Breeders’ Cup— those august, elite, and self-righteous bodies who always claim to know what’s best for racing—now find themselves arrayed against the National Horsemen’s Benevolent and Protective Association and the Association of Racing Commissioners International. The latter can be equally self-righteous and are accompanied by some state regulators, but have no august or elite pretensions. Quite the opposite, in fact, they claim to represent “the people.” Which is to say, bluntly, the non-elite. And let there be no mistake: in racing as in all things, the less-than-elite vastly outnumber the elite. The taking of sides we’re seeing leads to absurd ironies: one vocal HISA supporter dared to scorn the Kentucky HBPA for not being democratic enough…apparently not realizing that The Jockey Club, prime mover of HISA, is perhaps the least democratic organization on the globe, with the possible exception of the Catholic Church.
More importantly, the top of any sport’s pyramid is very, very tiny indeed, and
isolated, unless it has a broad and sturdy foundation with ready and fair access to the top. Those at the tip-top would do well to consider that fundamental fact. In American racing, remember that those graded stakes purses are funded by how much is bet on the overnights—meaning, for the most part, non-elite and lower level claiming races—which need robust field sizes to attract sufficient handle. Those are the trainers and owners represented by the organizations who are questioning the necessity and implementation of several supposed HISA “reforms.”
We hear these reasons for racing’s supposedly necessary reforms. First, we need to stamp out cheating. Second, we need to better protect the welfare of horses. Third, we need uniformity of racing rules throughout the country.
Following the experience of the last year or so, does anyone now seriously believe that adding a new layer of national bureaucratic and governmental oversight to the state oversight and regulation we’ve had since the 1930s will lead to greater uniformity, rather than more complexity, confusion, and cost? Predictably, uh, no. And, in the bargain, just what is happening to the total cost of racing regulation and oversight?
Equine welfare? To the extent that the rest of the nation expects to be required, for the most part, to follow California’s progress, this could be a positive. But is it outweighed by resulting confusion, misunderstanding, and outright resistance to its very necessity, practicality, and incremental costs? Why were so many complex regulations that were not in dispute replaced by even more intricate new language and protocols that indicate lack of fundamental horsemanship?

Finally, the worst self-inflicted wound, the perception that cheating is rampant in racing, repeated endlessly and without proof by The Jockey Club, in its anti-Lasix crusade. Yes, the authorities discovered and proved a cheating scandal via wiretaps intended for another purpose. So, please point us to the armor in the HISA hierarchy of complicated supervision that will prevent such an outrage from happening again.
What’s to be done? Well, we can continue to hope this bronc can be broke…and be thankful our cowboy is mounted on a horse instead of a tiger. If he is.

Sat, April 22 Californian Stakes (GII)
& Up, 1 1/8 Miles
Sat, April 22 Kona Gold Stakes (GIII)
4-Year-Olds & Up, 6 1/2 Furlongs
Sun, April 23 Siren Lure Stakes
4-Year-Olds & Up, 6 1/2 Furlongs (Hillside Turf)
Sat, April 29 Santa Maria Stakes (GII)
Sat,
Fillies and Mares 4-Year-Olds & Up, 1 1/16 Miles
Fillies, 3-Year-Olds, 6 1/2 Furlongs (Hillside Turf)
Sat, May 6 Lazaro Barrera Stakes
3-Year-Olds, 7 Furlongs
Sun, May 7 Singletary Stakes
3-Year-Olds, 1 1/8 Miles (Turf)
Sat, May 13 San Luis Rey Stakes (GIII)
4-Year-Olds & Up, 1 1/2 Miles (Hillside Turf)
Sat, May 20 Mizdirection Stakes
Fillies and Mares, 4-Year-Olds & Up, 6 1/2 Furlongs (Hillside Turf)
Sun, May 21 Desert Code Stakes $100,000 3-Year-Olds, 6 1/2 Furlongs (Hillside Turf)
Sat, May 27 Daytona Stakes (GIII) $100,000 4-Year-Olds & Up, 6 1/2 Furlongs (Hillside Turf)
Sat, May 27 Daytona Stakes (GIII) $100,000 4-Year-Olds & Up, 6 1/2 Furlongs (Hillside Turf)
Sat, May 27 Triple Bend Stakes (GII) $200,000 4-Year-Olds & Up, 7 Furlongs
Sat, May 27 Triple Bend Stakes (GII) $200,000 4-Year-Olds & Up, 7 Furlongs
Sun, May 28 Melair Stakes $150,000 Fillies, 3-Year-Olds, 1 1/16 Miles
Sun, May 28 Melair Stakes $150,000 Fillies, 3-Year-Olds, 1 1/16 Miles
Sun, May 28 Thor’s Echo Stakes $100,000 3-Year-Olds & Up, 6 Furlongs
Sun, May 28 Thor’s Echo Stakes $100,000 3-Year-Olds & Up, 6 Furlongs
Sun, May 28 Crystal Water Stakes $100,000
3-Year-Olds & Up, 1 Mile (Turf)
Sun, May 28 Fran’s Valentine Stakes $100,000 Fillies and Mares, 3-Year-Olds & Up, 1 Mile (Turf)
Sun, May 28 Snow Chief Stakes $150,000 Presented By City National Bank
3-Year-Olds, 1 1/8 Miles (Turf)
Mon, May 29 The Hollywood Gold Cup (GI) $400,000

3-Year-Olds & Up, 1 1/4 Miles
Mon, May 29 Shoemaker Mile (GI) $500,000 Breeders’ Cup “Win and You’re In” Challenge Race
3-Year-Olds & Up, 1 Mile (Turf)
Mon, May 29 Gamely Stakes (GI) $400,000 Fillies and Mares, 3-Year-Olds & Up, 1 1/8 Miles (Turf)
Sat, June 3 Summertime Oaks (GII) $200,000
Fillies, 3-Year-Olds, 1 1/16 Miles
Sun, June 4 Affirmed Stakes $100,000
3-Year-Olds, 1 1/16 Miles
Sat, June 10 Santa Margarita Stakes (GII) $200,000
Fillies and Mares, 3-Year-Olds & Up, 1 1/8 Miles
Sat, June 10 Honeymoon Stakes (GIII) $100,000 Fillies, 3-Year-Olds, 1 1/8 Miles (Turf)
Sun, June 11 Cinema Stakes $100,000
3-Year-Olds, 1 1/4 Miles (Hillside Turf)
Sat, June 17 Fasig-Tipton Futurity $100,000
2-Year-Olds, 5 Furlongs
Sat, June 17 Fasig-Tipton Debutante $100,000 Fillies, 2-Year-Olds, 5 Furlongs
Sat, June 17 Fasig-Tipton Debutante $100,000 Fillies, 2-Year-Olds, 5 Furlongs
Sun, June 18 Possibly Perfect Stakes $100,000 Fillies and Mares, 3-Year-Olds & Up, 1 1/4 Miles (Hill Side Turf)
Sun, June 18 Possibly Perfect Stakes $100,000 Fillies and Mares, 3-Year-Olds & Up, 1 1/4 Miles (Hill Side Turf)
Sun, June 18 San Juan Capistrano Stakes (GIII) $100,000
3-Year-Olds & Up, 1 3/4 Miles (Hillside Turf)
Sun, June 18 San Juan Capistrano Stakes (GIII) $100,000 3-Year-Olds & Up, 1 3/4 Miles (Hillside Turf)
Supplements available for all stakes Information on this document is subject to change.
Supplements available for all stakes Information on this document is subject to change.
**Cal-Bred Note
**Cal-Bred Note
FOR MORE INFO CONTACT JASON EGAN // DIR. OF RACING & RACING SECRETARY JASON.EGAN@SANTAANITA.COM // OFFICE: 626.574.6473
$300,000 THE GEORGE E. MITCHELL BLACK-EYED SUSAN STAKES - GII

Fillies - Three Year Olds // 1 and 1/8 Miles
$250,000 THE PIMLICO SPECIAL - GIII
Three Year Olds and Upward // 1 and 3/16 Miles
$150,000 THE MISS PREAKNESS STAKES - GIII

Fillies - Three Year Olds // Six Furlongs
$100,000 THE ALLAIRE DUPONT DISTAFF STAKES - LISTED
Fillies and Mares - Three Year Olds and Upward // 1 and 1/8 Miles
$100,000 THE HILLTOP STAKES
Fillies - Three Year Olds // 1 Mile // Turf
$100,000 THE VERY ONE STAKES
Fillies and Mares - Three Year Olds and Upward // 5 Furlongs // Turf
ALL STAKES WILL BE RUN WITHOUT THE USE OF LASIX
$1,500,000 GUARANTEED
THE PREAKNESS STAKES - GI


Three Year Olds // 1 and 3/16 Miles
$200,000 GUARANTEED
THE CHICK LANG STAKES - GIII
Three Year Olds // 6 Furlongs
$100,000 GUARANTEED
THE GALLORETTE STAKES - GIII
Fillies and Mares - Three Year Olds and Upward // 1 and 1/16 Miles // Turf
$100,000 GUARANTEED
THE JAMES W. MURPHY STAKES - LISTED
Three Year Olds // 1 Mile // Turf
$100,000 GUARANTEED
THE SKIPAT STAKES - LISTED
Fillies and Mares - Three Year Olds and Upward // 6 Furlongs
$200,000 GUARANTEED
THE DINNER PARTY STAKES - GIII
Three Year Olds and Upward // 1 and 1/8 Miles // Turf
$100,000 GUARANTEED
UAE President Cup (Arabian) - GI
Four Year Olds and Upward // 1 and 1/16 Miles
$100,000 GUARANTEED
THE MARYLAND SPRINT STAKES - GIII
Three Year Olds and Upward // 6 Furlongs
$100,000 GUARANTEED
THE JIM MCKAY TURF SPRINT - LISTED
Three Year Olds and Upward // 5 Furlongs // Turf
$100,000 GUARANTEED
THE SIR BARTON STAKES - (NWSS)
Three Year Olds // 1 and 1/16 Miles
ALL STAKES WILL BE RUN WITHOUT THE USE OF LASIX

Ihear people say win percentage doesn’t matter. That’s almost like saying batting average doesn’t matter,” said trainer Brad Cox, assessing the performance of trainer Brittany Russell, a former assistant.


Russell, training on the mid-Atlantic circuit, is, at the time of writing, winning at a 27% rate. Just as impressive for Russell if not more so, is consistency in her horses hitting the wire first.
Starting in 2020, her first year of saddling more than 100+ starters, her average for the three years is a sky-high 25%. If you translated that to a batting average, I’m not so sure she might be equaling Ted Williams’ .406 record.
Amazingly, 25% would constitute a “down year” for Russell. In 2020, her horses won at an astonishing 29% rate with purse earnings of over $1.6 million—her first year surpassing the sevenfigure mark.

Has any other trainer begun their career with this kind of success? A look at last year’s top 10 in earnings will surprise you. In their first three years of 100+ starters, the entire list, with the exception of Brad Cox, ironically, doesn’t top Russell’s career start.
When asked if she tracks things like win percentages, the affable Russell responded quickly with “No. I just try and do the barn and then go home and take care of my kids,” she said with a laugh.
Juggling a 40-horse barn at Laurel Race Course currently with another 30 horses stabled at Delaware Park plus raising a three-year-old and a seventeen-month-old, might be the most extraordinary accomplishment, however.


It is family that brought her to the mid-Atlantic circuit and her husband Sheldon Russell, a jockey on the circuit, who has kept her there.


“I made a decision to come back home to be close to my family [in Pennsylvania],” she said. “Sheldon and I were always good friends through the years, and we started seeing each other again. We knew pretty far into it that I was staying in Maryland, and we were going to get married.”
Family, both literal and figurative, has been part of both her profession and her personal life as a mom.
“The track opens here at 5:30, so I try not to be any later than the second set, which goes at 5:50.
“Sheldon and I get up, we get the bags packed, and get everything ready for the kids.” The Russells then head to the home of her assistant Luis Barajas’ mother, who lives only five minutes from Laurel Park. Barajas was Russell’s first hire and is considered a part of her family.
“Every day is a different schedule,” said Russell, adding that pickup time for the kids can be as early as 10 a.m. or as late as noon.





On Thursdays and Fridays, which are race days currently at Laurel along with weekends, the children stay at home with Sheldon’s mother, who lives with the Russells.
On race days on weekends, the Russells sometimes bring their children to the races.

Already, the oldest child, Edie, wants to be a jockey like her dad.
“He’s ‘super dad.’ Our daughter thinks he’s the best thing ever,” said Russell.
Brittany Russell’s introduction to horses and racing was much later than Edie’s. At age 12, she was on a field trip with a school class to a Thoroughbred horse farm near her hometown of Peach Bottom Pennsylvania. It was life-changing. “I saw it one time, and I wanted to work there,” she recalled.
Russell contacted the owner who put her to work where she learned the “hard work,” mucking stalls and cleaning buckets and other tack. The groundwork for her career was when she learned how to ride on the farm. “I learned horses through the racing side right away. I was cheap labor,” she added with a laugh.
Riding connected her to, perhaps, the biggest luminary in Russell’s career—Jonathan Sheppard, who trained near her home. “I galloped for him. I actually went to Keeneland for a short time for him between my farm days and college.
“He had a really unique style of training; he’d change it up.
“Some of these horses he’d send out over hurdles. One day, randomly, you had to be ready to pivot. If he sent you down to ride the hurdles, you did it.”
A key lesson learned from Sheppard that has impacted her training career was that good horses don’t all want to do the same thing every day.
Exercise riding was her entré into racing but not, however, the “safe route,” as she termed it, to be around horses. She pursued an associate’s degree in a veterinary technology program. “I thought maybe I’d work in a clinic or something and just be around horses.”

She was close to earning her associate’s degree when the lure of the racetrack was too much for her. Trainer Tim Ritchey at Delaware Park offered her an opportunity to come and gallop his

horses. Not long after, she was traveling to Oaklawn Park where she met Brad Cox and Ron Moquett—trainers who would figure prominently in her career.
It didn’t take long for exposure to training Thoroughbreds to replace any thoughts of becoming a jockey. “I loved riding, but it was never the lifestyle I wanted. I saw how hard it was to be a jockey and the battles with weight and all that.



“I definitely took to the training side of it,” she said. “Tim handed me responsibility pretty quickly because he probably realized I could do more than just gallop horses.
“He threw me into an assistant’s role, and it was sort of what I thrived on.”
Stints with Cox and Moquett followed. With each, as with Sheppard, she learned valuable lessons.
“There is a lot I picked up from Brad. He knows where to place horses. His care of horses is great.”

The most critical quality she saw in Cox, which is far more difficult than it sounds, was assessing his stock. “He just knew what he had,” said Russell of what she said is Cox’s uncanny ability to figure out the possibilities and limitations of each horse.



“I think that’s such a key to success. You can’t just learn that. You have to probably just have it.
If I hadn’t gone out on my own, I hope I’d still be there. He did a good job. He was so good to work for.”
Moquett, like Cox, imparted attention to detail and a goal of perfection. “They just take fantastic care of the horses,” she said. “The very best feed. The best vet care. The shedrow is immaculate.”

Moquett was instrumental in helping Russell hang her own shingle. “He decided to send a small string to Maryland, and I oversaw that.
“I wound up owning a few of my own that trickled in.”
Leaving Moquett and going out on her own, Russell almost immediately had a sizable stable with 23 horses—20 of which were from one owner. Unfortunately, that owner lived up to a reputation as someone who switched trainers often.
“He pulled them all. Boom. We were in tears, watching these horses leave. I’m going, ‘Oh my God, I’ve put all eggs in one basket.’ I’m thinking, ‘I’ll never build this back up.’”
“We just kept our heads down and kept working.”
“I was fortunate I still had some good connections. [Bloodstock agent] Liz Crow was awesome, sending me horses. I had 10 Strike Stables sending me some. Mike Ryan [an owner], literally kept my head above water for those first few months before I had more horses come in.”
One of them was a filly named Hello Beautiful. “I think I had five horses, and Hello Beautiful just launched me,” Russell said. “We actually owned half of her.”
The horse had an impressive win percentage of her own comparable, relatively, to her trainer. She won half of 20 starts, stringing together three straight wins twice in stakes races, and earning 100+ Equibase speed figures in eight of her 10 wins. She earned $587,820 in her career.
As important as the purse earnings was the attention she gained for Russell with other owners.

We offer every type of medical care your four-legged athlete could ever need. With board-certified specialists in all fields we provide everything from upper airway, arthroscopic and laparoscopic surgeries, to internal medicine, complex fracture fixation and advanced diagnostic imaging, including bone scans and MRIs — all in one place. It’s enough to make a human jealous.

800.724.5358
40 Frontage Road Ringoes, NJ 08551

www.midatlanticequine.com


The obvious and, to a large degree, unanswerable question is what Russell does to produce amazing results. “We go day to day. You can make a hundred wrong decisions, but tomorrow’s a new day.
“I think you have to make some mistakes to learn the right thing as well—maybe not where we place them, but in the general standpoint of training. We have to try different things to see what works. You’re probably going to make a lot more mistakes before anyone notices that you made the right decision.”
Another obvious question is if a bigger stage than the midAtlantic circuit is somewhere in her future. She just recently
won her first Gr.1 race—the Carter Handicap at Aqueduct with Doppelganger—the longest shot in the race at 18-1.


“I’m not looking past Maryland. Most of my business is built around Maryland. I have a full barn because we’re winning here and doing well here. People are sending me horses that fit here.

“You want to be bigger and better, go to bigger racetracks and win bigger races. Obviously, those are goals. But for the time being, I’m just trying to stay very grounded. I’m trying to do well where I am right now.”
“Well” as in win percentage. Wow.
Cox credits Russell for a major move in his career: New York. “Having her gave me the confidence, I would say, to go there. She played a big role with us getting our foot in the door in New York and obviously, staying there. She was the one that really kind of got things going for me in New York.”
“I’m very proud of what she’s accomplished,” he added. He also doesn’t think her success is attributable to being in Maryland. “I don’t think it really has anything to do with being in the mid-Atlantic. I think she’d be successful if her main base was New York or Kentucky. She gets it. That’s the bottom line.
The “it” he refers to is the intangible that a trainer either has or hasn’t.
Cox was emphatic in providing an anecdote of what he means: “Print this: I woke up this morning, and I had two horses I had marked to enter at Keeneland. I marked these races for these horses weeks ago. Today is the day of entry, and guess what? I’m not feeling it. We’re not running.
Brad Cox might be Russell’s biggest fan outside her family.
“Focus, attention to detail—basically the stuff it takes to be a good trainer; she’s on top of it. I could see it in the barn the first day she started working for us.
“We just were always kind of on the same page. If she was riding a horse, I always felt like maybe I was seeing what she was feeling in regard to the particular horse she was on.”
“I can totally understand where owners could be, ‘Well, what happened?’ Listen, they just don’t have it today. I’ve done this enough to know.”
Russell has stayed on the “same page” Cox talked about with her approach. “I think you have to trust your gut,” she said. “If I start second-guessing things, and I don’t know what to do about a certain scenario, you just have to trust your instincts.
“You get these feelings about horses, and you just have to go with them. It’s hard to explain.”
Hard to explain, but easy to see. Just look at the win percentage.







Botupharma combines Botucatu, a city in the State of Sao Paulo, where the company’s Headquarters is located, and its specialty Pharmaceuticals.
What is Botupharma’s origin and history?
Botupharma, as such, is not a startup company; about 20 years ago, three equine veterinarians and researchers at the State University of Sao Paulo (UNESP), also located in Botucatu, Brazil, came together to develop the very first products and materials for the newly created discipline of ART (Assisted Reproductive Technologies). As Botupharma became globally well-known for its extenders, the company naturally continued to develop products needed for ART, such as supplements supporting reproductive performance in stallions and mares, progressing to supplements for athletic performance horses and general health for adults and foals. In fact, being true pioneers for several products that, over time, became an industry standard for semen and embryo collection, manipulation, transport, and cryopreservation.
Considering the vast number of pharma companies out there, what makes Botupharma so different; what sets you apart?
The unique synergy of being an equine veterinarian with a profound understanding of equine nutritional demands while, at the same time, being a scientist became the foundation for developing highly effective products. Nevertheless, it does not stop here; all products are constantly field-tested by endless veterinarians on a day-to-day basis and in research institutes worldwide, allowing them to improve our products continuously. Thus, Botupharma products are not just simply based on science, as so many of our competitors like to claim, but Botupharma is the science behind its products. Furthermore, from purchasing the purest and highest quality ingredients to rigorous quality assurance procedures, including testing every batch before being sent to the end-user, it contributes to being the best. This dedication to animal health led Botupharma to be present on five continents, steadily growing its global presence.

Do you develop specific treatment management programs for clients when they present a veterinary prognosis?
Here in the US, our products are classified as supplements, thus, supporting, aiding, promoting, and enhancing physiological functions, growth, performance, and recovery. However, we do not treat an animal based on a veterinary prognosis. Our pharmaceutical line of products, for the time being, is only available throughout South and Central America and Mexico.
As we do not sell pharmaceutical-based products in the US for the time being, all our products offered in the US, Canada, the Caribbean, and Mexico are free to be purchased by anyone; you do not need to be a veterinarian. Although, it is recommended to consult with your vet about your nutritional plans for your animal.
What are the testing protocols you go through to bring a product to market?
Botupharma implemented several quality control steps, starting by assuring the quality of our prime materials come from trusted sources and are pure and clean when delivered; from there, it goes on to the production line, where modern equipment and highly-trained staff follow the manufacturing protocols until the finish line, where the products go through more inspections before being shipped. Furthermore, and a significant difference to many other manufacturers, every batch produced is tested before being liberated for sale. Trust is a critical decision-maker regarding which supplier and product to put your confidence in! Botupharma has proudly built this trustful relationship with its worldwide clients over the last two decades. Unfortunately, one must do his homework when it comes to choosing the right supplier and product because it is a known fact that several manufacturers are making false claims on their labels about the number and concentration of key ingredients, not to mention the lack of competent understanding of equine nutrition. Not just providing the advertised performance, but even more dangerous, may cause severe health problems and even death. Are there any withdrawal times (pre-race) for any of your products? And - Are all your products steroid free?
Excellent questions and imperative to choose your horse’s nutritional means. For all Botupharma products, there is no reason to interrupt your feeding protocol. All products are strictly developed, respecting the HISA Prohibited Substances List and Controlled Medications, and free of steroids and any substance considered doping.
What are the top three products you offer for the young racehorse?
Well, starting with the newborn foal, Botupharma offers “NEWBORN,” an oral paste supplement that offers superior nutritional support for the newborn and nursing foal. It contains a potent adsorbent that removes the toxins produced by infectious agents and boosts the immune system while preventing gastrointestinal disorders. After the initial phase, “Botumix Revitalize” aids foals under stressful situations, such as weaning, diet change, and diarrhea, given together with “Botumix Foal” (to be launched soon), will provide all the nutritional demands, stimulating muscle mass growth, especially for high-performance horses, to get them as close as possible to their maximum potential. After that, the supplement choice depends on the horse’s specific needs. For example, does an animal suffer from anemia? We provide “RedUp,” stimulating the production of red blood cells and recovery of the animal’s energy and vitality after intensive training. Alternatively, perhaps, the horse is with diarrhea; Botupharma’s “Entrin” offers complete nutritional support to assist gastrointestinal disorders in horses. The formulation combines prebiotics, toxins adsorbents, and glutamine to improve intestinal immunity and promote enterocyte recovery. For horses with joint problems, “Athroplus” for maximum mutual support, which we will add shortly to our supplement product line.
How long will it take to see a result once using your products?
Also, a great question, and of course, we need to consider first that the results vary from individual to individual, as well as the environment and daily training routine. Having said that, we know from many experiences and tests that the first effects occur within the first week of administration.
So what’s the next step? How can readers learn more about your product range and whom should they contact?
Botupharma entered the US market about five years ago to be hands-on and available for our North American customers due to the constant demand for our products. Headquartered in Phoenix, Arizona, our desire and commitment are to continue growing as a leading biotech for essential consumables for Assisted Reproductive Technology and the #1 choice for equine supplements, contributing to health, performance, and reproductive success. The reason for our growth is simple: Once customers have tried our product, – they will stay with Botupharma! As we are very enthusiastic and devoted to animal well-being and very confident about the outstanding performance of our products, proven time and again, we offer free samples for the ones who are sincerely interested in testing our products. Our Webpage: www.botupharmausa.com, is a good source for more information about the company and its products. Please, feel free to contact sales@botupharmausa.com to learn more about it.

Ben Colebrook spent his 45th birthday eating a slice of pizza alone on a Friday night in Brooklyn. He was in New York on an overnight trip from Kentucky for a show the next afternoon in which his Raise Cain was given odds of having little more than a walk-on part. Despite expecting a strong performance, Colebrook didn’t stay for the closing curtain.
Once he’d given José Lezcano a leg up in the saddle, Colebrook headed out of the track’s front gate, where an Uber was waiting for him. The car idled long enough for the trainer to get a live view of the field leaving the starting gate. He watched the rest of the race on his phone, and that’s how he saw his 23-1 shot win the Gr.3 Gotham by 7½ lengths, guaranteeing Raise Cain enough points to qualify for a start in the Kentucky Derby.


As the Uber drove from Aqueduct to Kennedy International Airport and maneuvered traffic less eventful than Raise Cain’s stretch run around Howgreatisnate, who’d thrown his rider at the start, the bay son of Violence was joined in the winner’s circle by only his jockey, groom, and a barely visible valet. Colebrook began to receive texts. “Are you OK? What happened?”
Colebrook was fine. He’d ducked out early because he didn’t want to miss his flight to Cincinnati, just across the Ohio-Kentucky state line from Turfway Park, where he had Scoobie Quando, also on the prowl for Derby points, entered in the John Battaglia Memorial Stakes later that night.

His runners didn’t pull off the stakes double. Scoobie Quando was second in a field of 12—a good effort in only his third start. The original plan was to keep the colts, both owned by Andrew and Rania Warren, apart for their next races; but when Scoobie Quando had to scratch from Turfway’s Gr.3 Jeff Ruby Steaks for a minor issue, it meant he’d need to connect a Hail Mary pass to score a Derby saddle towel. The Gr.2 Wood Memorial at Aqueduct and the Gr.1 Toyota Blue Grass at Keeneland on the same day had enough points up for grabs, and after weighing their options, they decided to stay home and enter Raise Cain and Scoobie Quando in the Blue Grass. Colebrook would gladly have taken a win in either race, but as he says, “The Wood Memorial would be great to have on your resume, but I’m a Keeneland guy.”
Indeed.
Ben Colebrook trains out of Keeneland’s year-round Rice Road barns, on the other side of the street from the main facility. “Keeneland’s part of the reason why I’ve had, if you can call it a successful career, it’s been because of being stabled at Keeneland. It’s probably the major reason why I’ve gotten horses. People want to have their horses here, and there’s only so many stalls down there on Rice Road.”


The son of now-retired farm manager John, who trained a few horses on the side and compiled a record of 18 wins in 140 starts from 1991–1995 and 2007–2012, and Mary Jo, Colebrook is the oldest of two sons. By the time his father was yearling manager at Don and Mira Ball’s Donamire Farm in Lexington, Ky., fouryear-old Ben would get on the pony and ride around the farm’s private training track. But as he grew older, Colebrook considered taking a different direction with his life. “I was trying to get away from horses.” He laughs. He paid his own way through a few

years at the University of Kentucky, pursuing a business degree while getting on horses around his class schedule. “Burning the candle at both ends,” he says.
“Horse racing gets in your blood. It’s sticky. I tried to be normal and have a normal life…” After a pause, he adds, “It didn’t really take.” The allure was too great. He left college without graduating.
“Sometimes,” he says, “you wish you just would have stayed in school, but I don’t know. There’s good days and bad days, obviously. But then at this stage, you’re pretty much committed anyway. Literally committed. Or,” he jokes, “should be committed.”
Most folks entrenched in a precarious 24/7/365 business can understand the latter sentiment, even if it’s meant tongue in cheek. In an alternate reality, Colebrook, true to his easy going personality, would have liked to be a “ski bum” in Colorado. “I’d have to be doing something outside. I’d go postal working in an office.”
Instead, his office is his pickup, the track rail, and the Keeneland grandstand. It’s not the Rockies, but it sure beats a cubicle—and he still makes time to go skiing every winter anyway. His “assistant,” Cash, a five-year-old black Lab, keeps morale high from the backseat of the truck. “He’s excited in the morning. At 4:30, he’s all, ‘Come on, let’s go!’”
Colebrook came up under numerous good horsemen, including Bill Harrigan, Fred Seitz, Hall of Famer John Veitch, and Christophe Clement.
Harrigan liked what he saw in young Colebrook, who juggled getting on Harrigan’s horses while going to the UK. “Ben’s kind of a family member of ours; that’s how we feel,” says Harrigan, who
broke and handled the pre-training of Horses of the Year A.P. Indy and Mineshaft and currently has a two-year-old homebred in Colebrook’s barn. “He always got along great with horses, was very interested in it, and was a super guy to have around because of his personality. Those are the kind of guys that go on to make it. They’re happy in their job, and they’re interested in their job and they like to work.”
In 2002, Colebrook traveled to Saratoga with a steeplechaser for Harrigan and farm trainer Mark McEntee. McEntee was friends with Clement from the time both worked for trainer Shug McGaughey, so when one of Clement’s riders got hurt, Colebrook got on some horses to help out McEntee’s old friend. Colebrook and Clement stayed in touch, and by 2007, Clement convinced him to join his team. “I never really wanted to go to New York, so I was kind of reluctant,” says Colebrook. “When we talked about it more, I said, ‘I like central Kentucky, and this is where I want to be.’”
Clement set up his new assistant at Keeneland, sending him two-year-olds and lay-ups. Colebrook says, “Christophe really liked the synthetic track for the babies because he didn’t have to miss any time for the weather. You’d ship horses to Saratoga, and it would rain for weeks and he wouldn’t be able to get a line on his babies, so it worked out really well for him here.”



He oversaw a Kentucky division for Clement for nearly five years. By then, says Colebrook, “It got to the point where it was time for me to do something on my own. And Christophe was good about it; he helped me out.”
Things began to fall into place.

The Ball family’s Donamire Farm was among Colebrook’s first owners, and to this day their support has been unwavering. For two decades, Katherine “Kay Kay” Ball, who’d met her husband Mike through John Colebrook, trained many of their horses herself, but she was ready to give Colebrook his shot. “I was always asking Ben when he was going to start training,” Ball says. When he called to tell her, she said, “Can you come to the barn?” Ten minutes later, she was showing him a filly, asking him if he wanted to train her. He did.
Colebook prepared to take his trainer’s test. The day he walked into the racing office, his former boss John Veitch, by then a Kentucky state steward, was sitting in there. Veitch asked, “Did you read the book? Did you study? Are you going to pass?” Colebrook said, “I think so.”

Veitch told him, “Go in there and get your damn license.”
This was during the era when the main track at Keeneland was a synthetic, all-weather surface, and not as many people were willing to train over it full time, so Colebrook was allocated space on Rice Road after another trainer was suspended and lost his stalls. “I snuck in. I was so lucky,” he says.
Colebrook started off slowly with his own stable—paying tribute to his mentor by training, Clement-style, in quarter sheets—while keeping a few horses for Clement. He made one start in 2012 and two late in the spring of 2013. But by autumn, he was better prepared; his first horse to hit the board was Donamire’s Holiday Stroll, third in a maiden at Kentucky Downs in September. In October, he saddled his first starters at Keeneland, breaking his career maiden with Mt Tronador for Darrell and Lendy Brown and English Estate. Colebrook’s runners also came in second twice and fourth once that month, from all his starters at the meet.


“I had four runners at Keeneland, and they all ran good. I’m thinking I’m like the big man on campus there until [Keeneland’s then-director of racing Rogers] Beasley called me into his office one day. He said, ‘How many horses did you run?’ I said, ‘Four.’ He said, ‘You have 15 stalls. Do you think that was enough starts?’ I called Christophe afterwards and I said, ‘Man, I’m going to have to hustle and get some horses here after the talking-to I just got.’ And the next meet at Keeneland, I don’t know how many horses I ran— anything with a mane or a tail—and I won a race. The next fall, I won the [Gr.3] Valley View [at Keeneland], and after that, it was pretty good with Beasley. I didn’t blame him. Those stalls are gold.”

Keeneland has been the scene of Colebrook’s milestones: in 2013, his first win; in 2014, his first Graded win, in the Valley View with Sparkling Review, who later won the Gr.2 Mrs. Revere at Churchill Downs; and in 2018, his first Gr.1 win.
He doesn’t love to talk about that Gr.1 winner, Knicks Go.
Colebrook trained Knicks Go for the Korea Racing Authority during the colt’s two- and three-year-old campaigns. They won Keeneland’s Gr.1 Claiborne Breeders’ Futurity by 5½ lengths at 70-1 and were a 40-1 second in the Sentient Jet Breeders’ Cup Juvenile.
“I was probably a little naïve with him. He was so fast and so hard on himself in the morning, and I just kept thinking, ‘You’ve gotta get this horse to relax.’”
Knicks Go made six starts, five in stakes, in a five-month span as a two-year-old and eight times—seven stakes—from February to November at three. Colebrook kept advising the owners that the colt needed a break, but they wanted to keep going. “He just lost his confidence and I…” he pauses, “I started to lose my mind.”
After his final start at three, Knicks Go—who was Horse of the Year at five—was switched over to Brad Cox. “He ran one big race with Brad [at allowance level], and then he got hurt and got more time off. Brad had a fresh horse and just got to send him, and that’s probably what he always wanted to do. But it is what it is.”
Colebrook is happier to talk about the Ball homebred Limousine Liberal, who ran in Kay Kay Ball’s colors and won or placed 22 times in 27 starts, from 2015-2019. “The coolest thing about him is you didn’t need to worry about him; you didn’t worry if he was going to run his race today. You never know when you bring a horse over if they’re going to show up, but he always did. He was like an ATM machine,” he says.
The Successful Appeal sprinter set track records at Ellis Park and Keeneland, notched three Gr.2 races and a Gr.3 among his six stakes wins, and was second or third in 13 other Graded stakes—four of them Gr.1’s. He made his stakes debut in his third lifetime start, finishing second behind eventual champion sprinter Runhappy in the Gr.1 King’s Bishop at Saratoga.
Limousine Liberal was on the board—including a second by a nose, a second by a neck, and a third by a nose and a neck—in seven of eight tries at Keeneland; but he only won there once, in an allowance optional claimer. After one of those narrow losses, Mira Ball—the matriarch of the Donamire family—pulled Colebrook aside to tell him that the farm is “cursed” in Graded races at Keeneland. “Your horse ran awesome today,” she said. “I’m really proud of you, and I just want you to know it’s not your fault.”
For his part, Colebrook was just as proud to give something back to the Ball family. “Donamire hadn’t had a good horse in forever, and Mike and Kay Kay had never really had a good one on their own, so Limousine Liberal definitely put the wind in everybody’s sails again. Kay Kay’s all in all the time, but you know, when you’re not having any luck, it’s not any fun.”
He also trained Edward Seltzer and Beverly Anderson’s Gr.3 Arlington Classic winner Surgical Strike, as well as the LNJ Foxwoods filly Fancy Dress Party, whose five wins in six starts include the Gr.3 Beaumont at Keeneland.
The Limousine Liberal years were a particular high point for Colebrook. “When I got Cash” (that’s his dog; he and wife Marina also have a mini-Aussie, Luna),“I knew I was in for a dry spell,” he says. “Limousine Liberal won the [Gr.2] Belmont Sprint Championship, and I picked Cash up—I got him from a breeder in New York—and got on a private plane with Kay Kay and flew back home. I don’t think you could have a much better day than that: get a new dog, win a Graded stake, and fly back on a private jet. I knew that I’d be paying for that, with the highs and lows—that there would be some big lows.”



That’s the natural cycle of the business: an abundance of lows relative to the highs—more so for a trainer with a small-to-medium stable, which, in Colebrook’s case, is by choice. He hopes simply to maintain what he considers a manageable stable of 50—his “sweet spot.”

He says, “Any more than that, I can’t find the help to do it. Right after Sparkling Review, I got a lot of horses. It all happened so fast, and suddenly, I had 70 horses. If I could have them all in one place it would be different, but I don’t want to have all these strings everywhere and a bunch of assistants. It wasn’t my cup of tea.
“But in saying that, it’s hard to maintain a medium-sized stable. If you limit your size, you’re going to get less good horses, and then you hit dry spells where you don’t have any good horses. I could have taken that next step and tried to get 100. Horses are probably the easy part,” he says. “It’s getting the good horses in the barn that’s the hard part. I think also numbers erase mistakes, so if you have 100 horses and you make a couple of mistakes with some good three-year-olds or two-year-olds, they don’t get noticed. But if you don’t have that many and make some mistakes, you don’t have any horses. It’s a numbers game after all, unfortunately.”
Colebrook has done enough right with Raise Cain that, all being well, the colt is poised to become his first starter in a Triple Crown race. Although he was only fifth in the Blue Grass, he ran wide and covered a lot of extra ground to put in an encouraging closing move, clocking the final eighth faster than any but the first two home. Scoobie Quando finished
ninth, ending all hope that Colebrook and the Warrens would have two in the Derby; but in this numbers game, one Kentucky Derby starter is more than most people get in their lifetime.
Although the Warren surname is well known in association with 2005 Horse of the Year Saint Liam and 2018 Breeders’ Cup Dirt Mile winner City of Light, those horses ran for Andrew Warren’s parents, William Jr. and Suzanne. This is only Andrew and Rania Warren’s third crop of three-year-olds under their banner: in January, Scoobie Quando became their first stakes winner, while just two months later, Raise Cain was their first Graded stakes


winner. They’d been introduced to Colebrook by veterinarian Greg Fox, a former trainer who’s now the U.S. representative for the Australian company E-Trakka. Heart rate, speed, stride length, and other data from all the Warren trainees is monitored using E-Trakka pads during their breezes, as a complement to what the trainer sees visually.
No data is required to recognize that Colebrook’s profile is on the ascent again, but he’s been grinding long enough to know that moments like this are not the norm. On freezing winter mornings, the rail on the all-weather training track at Keeneland is a lonely place. With a laugh, he says that his goals are to “make payroll, pay bills.”

Of course he has loftier aspirations than that, but the reality is that while such modest goals may seem self-deprecating, it’s a reflection of the state of the industry, which relies heavily on its being a labor of love at every level. He says, “The horse business and horse racing have gone two separate ways, and it’s become too much of a business and not enough of a sport and a passion for people.”
It’s not getting any easier.
With the Horseracing Integrity and Safety Authority (HISA) in place now, one uncertainty moving forward has replaced the previously existing uncertainty moving forward. Colebrook approaches government oversight with an open mind. “I went to all the meetings about the Horse Racing Integrity Act, so I would say I was a supporter of it for sure, but when it launched, I just felt like there was a big disconnect,” he says.
“I felt like they were listening to very few voices. I talked to [HISA chief executive officer Lisa Lazarus, and to be honest, it
set my mind at ease a little bit that they are starting to realize that maybe they don’t know everything, and that trainers aren’t all Jorge Navarro and Jason Servis. The industry has done a terrible job policing itself, but I think that now they realize that the more voices and the more people that you can listen to is a good thing. They put people on there that were also anti-HISA, so I think that’s good because if you’re just going to be a sounding board for it, that’s not really what they need to hear. Everybody sees the world through their own point of view, and if you’re only looking at it one way, you’re probably going to miss a lot. And if you take a lot of vantage points and put them all together, you might get to the actual issues and what needs to be changed.”
One thing he would like to see differently is other areas of the industry taking more responsibility for problems created before the horses even reach trainers. “It’s fine to have us change everything we’ve done,” he says, “but I think we need to look at how we’re raising and breeding horses. What has more of an effect on soundness: breeding a mare that made one or two starts to a stallion that made one or two starts, or the fact that that stallion ran on Lasix? Whether you’re pro-Lasix or anti-Lasix, it’s the one thing that divides everybody. I think they could agree on 99% of the other stuff. Nobody wants cheaters. Everyone wants horse welfare, aftercare. All these are things that if you don’t agree with, why are you in the horse business?”
As for Colebrook, well, there’s no great mystery as to why a kid who started out riding a pony around a farm track just a few miles down the winding back roads of Keeneland is in the horse business. That he should end up where he is now, making a name for himself so close to where it all began, is his success story.

Years ago, when he first ran a horse for Donamire, someone asked one of the Balls, “Who the hell is Ben Colebrook? Why’d you send him a horse?”

Regardless of what happens in the Classics this year, by now, no one needs to wonder anymore.




FREE TO MOVE is more than just a comprehensive joint health portfolio from Boehringer Ingelheim. It’s how we want every horse to feel.
From elite athletes to backyard companions, when sidelined by joint disease, that horse lives in the shadows of its former self. It’s painful for them, and heartbreaking for you.
As an industry leader in joint health, we go beyond providing a trusted lineup of flexible solutions. We offer education and support, so you can understand the ins and outs of joint health and feel confident your horse is receiving the best care.
Learn more about our joint health solutions at THEARTOFHORSE.COM
EQUIOXX IMPORTANT SAFETY INFORMATION: As a class, nonsteroidal anti inflammatory drugs may be associated with gastrointestinal, hepatic and renal toxicity. Use with other NSAIDs, corticosteroids or nephrotoxic medication should be avoided.
LEGEND IMPORTANT SAFETY INFORMATION: The following adverse reactions have been reported following intravenous injection: occasional depression, lethargy, and fever. Following intra-articular injection: lameness, joint effusion, joint or injection site swelling, and joint pain.
HYALOVET and HYVISC IMPORTANT SAFETY INFORMATION: A mild inflammatory response may occur post injection. For intra-articular injection in horses only. Do not use in horses intended for food. Caution: Federal law restricts this drug to use by or on the order of a licensed veterinarian.
SURPASS IMPORTANT SAFETY INFORMATION: SURPASS topical cream is only approved for use in horses and has not been evaluated in breeding, pregnant, or lactating horses, or in horses under 1 year of age. Do not exceed the recommended dose.


$10 million per year in lost training and racing days.
Often a frustration to trainers and owners, this problem rears its ugly head at the time of highest expectations, such as arising the last day of work before a horse’s first race, right after a horse’s first victory or after a horse was purchased at a two-year-old sale.
This disease presents with heat, pain with or without inflammation (swelling) on the dorsal (front) surface or the dorsomedial (front inside) surface of the third metacarpal bone (cannon), which is referred to as acute periostitis. With rest and reduced exercise, the condition can improve, but catastrophic fractures of the cannon may occur at the site of previous DMD episodes. A good understanding of this disease and strategies of prevention are vital in order to improve the welfare of the horse and reduce the potential expenses to all shareholders.
The cannon bone is an important structure in the weight bearing and absorbing shock. As the horse moves, the bone bends a little and then returns to its original shape like an elastic band, which is often referred to as elastic deformation. In addition, it has been observed that horses that work slowly have tension on the front of the cannon bone; in other words, the bone is stressed by a stretching force rather than a compressing force. However, at higher speeds, these forces change from stretching to compressing forces.



Repeated bending forces (stress cycle) on the cannon bone causes dorsal metatarsal disease. When the horse is young, it has a thin bone cortex. As the horse grows and is repeatedly subjected to these forces, the bones remodel and the cortex thickens, making it stronger. However, if the bending forces exceed the bone’s ability to remodel, then this leads to stress fatigue and bone damage.

of
training and racing days in racehorses is dorsal metacarpal disease (DMD), often referred to as “bucked shins” or “sore shins.” In the United States, this problem has been estimated to cost
ABOVE: DMD occurs most commonly in 2- to 3-year-olds, often within their first 6 months of training. It is rarely seen in horses with a mature skeleton.
The occurrence of bucked shins is most common when horses are developing, typically at two to three years old as training becomes more intensive. But it must be noted that if the horse is not bone fit, any aged racehorse is susceptible to these diseases when they begin training. Roughly at the age of five years, when a horse is fit, they are at a low risk of this disease. Within the first six months of training, DMD may present in one or both front limbs. If the condition does occur in both front limbs and the horse is being trained on a circular track, then it is likely the inside leg is where it will occur first. In other words, if the training tends to be in a counterclockwise training circuit, then there are greater forces on the left limb than the right, thus the left is more likely to develop the disease before the right limb.
Age: DMD occurs most commonly in two to three-year-olds often within their first six months of training. It is rarely seen in horses with a mature skeleton (age four and over). However, this disease has been seen in five-year-olds especially if they have been stalled for a long amount of time after weaning and not racing until that age.
Gender: It is believed that the gender of the horse does not alter its risk to DMD.
Breed: Most common in Thoroughbreds but may be seen in both Standardbreds and Quarter horses.
Genetics: The risk of DMD is influenced by genetics as variation in limb bone geometry (inherited) behaves differently to force/ strains on the bone. In addition, the longer the cannon bone, the greater the load is at flexion of the dorsal cortex of the bone, making it more susceptible to DMD.
Training and racing surfaces: The different types of training and racing surface alter the risk to DMD because there are variations in the force applied to limbs as well as the acceleration rates of hoof impact. Furthermore, the impact of these forces is increased with greater speed. Dirt tracks tend to be the hardest surface, whereas synthetic tracks reduce hoof and limb impact and loading force. However, it is important to remember that the hardness all of these surfaces can be altered by a number of other factors such as:


• Different surface materials
• Changes in weather, temperature and humidity
• Surface maintenance (i.e., soaking, harrowing)
• Changes in horse body weight
• Age of surface, wear and tear of surface
• Human opinion of condition of track


To prepare a horse for peak performance while avoiding injury, you need to know how the athletes' bones respond to training. That’s why Hagyard Equine Medical Institute is proud to partner with Churchill Downs Racetrack to make MILE-PET – the first dedicated equine Positron Emission Tomography (PET) scanner– available to assist your team in providing the most advanced imaging available trackside in Kentucky
Equine PET scans are performed standing while using light sedation The lower limbs can be efficiently scanned and the fetlock, an area most commonly imaged, can be done in less than five minutes, with all four in less than 30 minutes The result is a high-quality image that helps find potential abnormalities and allows trainers and their veterinarians the ability to formulate the best training plan for the horse.


Access this state-of-the-art technology to help you unlock the full potential of your horse For more information or to schedule an appointment, call (859) 233-0026.

 MILE-PET image of a fetlock with no abnormalities
MILE-PET image of a fetlock with condyle and sesamoid lesions
MILE-PET image of a fetlock with no abnormalities
MILE-PET image of a fetlock with condyle and sesamoid lesions
Training: The length of time for bones to respond to different training practices is unknown. Although further research is required, it is suggested that fast work should be avoided in the early stages of training as it is thought that high-speed exercise introduced too quickly (within one month) was detrimental to bone health.
Direction of training: Track direction varies globally. Thoroughbreds tend to lead with the inside forelimb around turns then switch to the outer forelimb on the straight. It has been suggested that due to greater forces on the leading limb on the turn, that limb is more at risk of bucked shins. However, more research is required to make accurate conclusions.
Speed: Current research is contradictory. Some research indicates a reduction in the risk of DMD if the horse is trained at high speeds with every extra mile worked, and canter work increases the risk. However, other research suggests that short periods of work (< 1 month) at high speed increases the risk of DMD.


Camber: In the U.S., tracks are usually flat in contrast with European tracks, which tend to vary in their design and often include slopes, twists, turns, uphill sections, and cambers, with turf being the prevalent surface. In addition, races may be run straight, clockwise or counterclockwise. Although it is known that this variation in track characteristics alters the horse’s gait, thus altering forces on the forelimbs, further research is needed to understand if these variations increase the risk of DMD.
Bucked shin is the formation of tiny stress fractures on the front or inside of the cannon bone of the horse’s front legs. DMD occurs when the stress on the legs with high-speed training exceeds the bone’s ability to adapt to those stresses.

Bone is a dynamic tissue that is constantly adapting its structure. Once the bone is formed in immature animals, the bone grows and changes shape by a process called modeling. Bone remodeling is different to modeling in that its function is to renew the skeleton and involves both bone resorption and formation to occur at the same location in a sequential manner.
With high-speed training, there is high-strain fatigue, which causes excessive compression of the bone. During this compression, there is an insufficient amount of bone remodeling at the point of stress. At this site, this new bone is much weaker; thus, it is susceptible to inflammation, and pain and may lead to fractures.
Treatment of DMD is designed to alleviate pain and inflammation while allowing the remodeling process of the bone to catch up with the damage that has been caused from stress cycling.
The core of the treatment is rest and providing pain relief, followed by a slow and gradual increase in exercise levels.
Trusted by veterinarians for over 20 years.

CHONDROPROTEC®, a sterile solution containing 1000 mg polysulfated glycosaminoglycan per 10 mL
HYCOAT® 10 mL, a sterile solution containing 50 mg sodium hyaluronate per 10 mL (5 mg/mL), AVG REL MW > 1.0 MM Daltons
HYCOAT 2 mL, a sterile solution containing 20 mg sodium hyaluronate per 2 mL (10 mg/mL), AVG REL MW 1.0 – 1.3 MM Daltons

Fractures of the bone cortex can be treated with surgery using lag screw fixation and osteostixis. Osteostixis is the drilling of many holes around the site of fracture in order to promote bone healing. Lag screw fixation is the drilling of a screw across the fracture line to compress and stabilize the bone. However, fracture recurrence is common with both techniques and requires five to six months out of training. There are additional treatments that may be used to complement core treatments. Extracorporeal shock wave therapy (ESWT) is commonly used for treatment and involves a highly concentrated, powerful acoustic (sound) energy source being applied to the site of injury. The rationale is that ESWT increases blood flow, increases growth of new blood vessels and increases the production of natural healing factors in the treated area. The research findings are limited on its effectiveness but anecdotally among the veterinary profession, it seems to work on bucked shins and stress fractures.
In North America, horses are not permitted to race or breeze for 30 days following treatment as per the Horseracing Integrity and Safety Authority’s (HISA) rulings. In Europe, horses must not have had shock wave therapy on the day of racing, or on any of the five days before the race day in which the horse is declared to run.
With all treatment options, there must be a careful and considered discussion with the veterinarian and all stakeholders on the desired outcome while bearing in mind the important factor of the horse’s welfare and wellbeing.

Some clinicians are using a combination of shockwave and bisphosphonates (Tildren™, OsPhos™) to treat DMD. Bisphosphonates were first seen in human medicine and used for osteoporosis. Bones are constantly remodeling in a process that removes old bone cells and deposits new ones. Bisphosphonates help prevent bones from losing calcium and other minerals by slowing or stopping that natural process that dissolves bone tissue, thus, helping bones remain strong and intact. Veterinary surgeons report mixed results with these therapies, and long-term use of bisphosphonates is expensive and has serious consequences. Bisphosphonates are toxic to the gastrointestinal and renal systems, thus, potentially causing colic and kidney disease. Their safety has not been evaluated for the use in horses younger than four years old nor in pregnant and lactating mares.
HISA’s Anti-Doping and Medication Control (ADMC) Program came into effect on March 27 and with it, new regulations regarding the presence and use of bisphosphonates.
The Horseracing Integrity & Welfare Unit (HIWU) states “The ADMC Program regulations categorize bisphosphonates as a banned substance, meaning that they are prohibited from being administered to, or present in, covered horses at any time. Covered horses that test positive for bisphosphonates under the ADMC Program are subject to lifetime ineligibility, and associated covered persons may incur an Anti-Doping Rule Violation.”

“HIWU will not pursue disciplinary action against Covered Horses or their associated covered person(s) for the presence of bisphosphonates if the covered person(s) can provide documentation (e.g., medical records or a positive test result) to HIWU of the administration or presence of bisphosphonates prior to the implementation date of the ADMC Program.”
In Europe, bisphosphonates are not to be administered to a racehorse under the age of three years and six months as determined by its recorded date of birth, on the day of the race or on any of the 30 days before the day of the race in which the horse is declared to run as per The International Federation of Horseracing Authorities rulings.
“My 24-year-old Thoroughbred, Dylan, broke his leg (Olecranon fracture) in May. My vets were amazed at the quick progress after we started Dylan on OCD Pellets.They said the improvement was remarkable and were impressed that he was still alive! Thank you, Doc’s and OCD Pellets. YOU SAVED MY HORSE DYLAN’S LIFE.”






With DMD, it must be remembered that it is an appropriate response for new bone formation when the cannon endures cyclic stress and injury. This injury cannot be ignored but addressed to reduce the risk of serious consequences. Exercise is the root of the problem; therefore, the solution is to alter the patterns of exercise.
Dr. David Nunamaker, DVM, of the University of Pennsylvania, has developed a training program, which is believed to reduce the risk of DMD. The rationale when developing this modified training program is that horses are not born with the right bone structure for racing. The bones are to develop and adapt to racing. By providing training programs that mimic racing, the bones can adapt to the forces that are applied during racing, thus, reducing the risk of developing bucked shins.
When initiating this training regimen, it is assumed that young horses are broken to ride in autumn and able to gallop a mile by January so that training can start.
• Stage 1 (5-week duration)
Horses finish the gallops two times a week with the last 1/8th of the mile (last 200 meters of 1600 meters) completed in an open gallop in 15 seconds.

• Stage 2 (5-week duration)
Twice a week, open gallops for ¼ of a mile (400 meters of 1600 meters) in 30 seconds including a one-mile (1600 meters) gallop.
• Stage 3 (7-week duration)
The addition of speed work once per week. Breezing (moderate speed) for ¼ mile (400 meters) and daily gallops lengthened to 1¼ miles twice per week for four weeks. In the following three weeks, the ¼ mile breeze is continued with a strong gallop out for another furlong (roughly 40 seconds total for a breeze).
The findings of exercise research are often varied and contradictory due to many research variables, making comparisons and conclusions difficult. In addition, most of the research of musculoskeletal issues in racehorses uses racing data, but most injuries occur during training.
Because more research is needed, there remain conflicting views of the effects of racing on horses before skeletal maturity and the most effective and safe way to introduce speed exercise. At present, the data suggests that distance and speed should be implemented gradually and should include high-speed work at full racing speed.
The racing industry must continue to work cooperatively to address the welfare concerns associated with horses experiencing DMD.

The standard of equestrian excellence since 1929


VICTORY MODEL ALL SURFACES DIRT
SPORT QUEENS FRONT & HIND
PROMOTE
YOUR
EC QUEENS FRONT & HIND
ALL SURFACES
VICTORY MODEL DIRT
THE FEED & NUTRITION GUIDE 2023

SPORT QUEENS FRONT & HIND
EC QUEENS FRONT – SOLID HEEL
EC QUEENS FRONT & HIND
EC QUEENS WEDGE FRONT & HIND
EC QUEENS 3-DEGREE WEDGE HIND
EC QUEENS FRONT - SOLID HEEL
RX FRONT & HIND
EC QUEENS WEDGE FRONT & HIND
SPORT XLT HIND
EC QUEENS 3-DEGREE WEDGE HIND
SPORT XLT WEDGE HIND


This invaluable and easy-to-use reference guide to supplements and feeds is purposely designed with trainers and breeders in mind, with products categorised by their areas of application.

RX FRONT & HIND
EC XLT HIND
VICTORY MODEL DIRT
EC XLT 3-DEGREE WEDGE HIND
SPORT XLT HIND
SPORT QUEENS FRONT & HIND
ALL SURFACES
RX XLT HIND
Look out for the guide in the next issue of European Trainer!
EC QUEENS FRONT & HIND
SPORT XLT WEDGE HIND
EC QUEENS FRONT - SOLID HEEL
EC XLT HIND
EC QUEENS WEDGE FRONT & HIND
EFFECTIVE DATE FOR THE HISA SHOEING RULES AND THE “NON-ENFORCEMENT” GUIDANCE – AUGUST 1, 2022 VISIT HISAUS.ORG FOR UPDATED INFORMATION
EC XLT 3-DEGREE WEDGE HIND
EC QUEENS 3-DEGREE WEDGE HIND
RX XLT HIND
RX FRONT & HIND
SPORT XLT HIND
SPORT XLT WEDGE HIND
EC XLT HIND
EC XLT 3-DEGREE WEDGE HIND
RX XLT HIND
EFFECTIVE DATE FOR THE HISA SHOEING RULES AND THE "NON-ENFORCEMENT" GUIDANCE - AUGUST 1, 2022
VISIT HISAUS ORG FOR UPDATED INFORMATION
EFFECTIVE DATE FOR THE HISA SHOEING RULES AND THE "NON-ENFORCEMENT" GUIDANCE - AUGUST 1, 2022
VISIT HISAUS ORG FOR UPDATED INFORMATION
WORLDWIDE WE HAVE 300+ DEALERS AND DISTRIBUTORS OF OUR VICTORY PRODUCTS FOR MORE INFORMATION PLEASE SCAN THE QR CODE OR VISIT VICTORYRACINGPLATE.COM



The leading causes of horse mortality can be attributed to gastrointestinal diseases. Therefore, maintaining the balance of the gut microbiota and avoiding a shift in microbial populations can contribute to improved health status. The gut microbiota, however, can be influenced by countless dynamic events: diet, exercise, stress, illness, helminth infections, aging, environment and notably, antimicrobial therapy (antibiotics). These events can lead to gut dysbiosis—a fluctuation or disturbance in the population of microorganisms of the gut, which can contribute to a wide range of disease. The use of antibiotics in horses is thought to have one of the most notable effects on the gut microbiota (gut dysbiosis), which can lead to diseases such as colitis, colic and laminitis.
Antibiotics, which are antimicrobial agents active against bacteria, are important to equine medicine; and bacterial infections can be resolved quite successfully using antibiotics for antimicrobial therapy, but there are consequences to their use. An antimicrobial agent can be defined as a natural or synthetic substance that kills or inhibits the growth of microorganisms such as bacteria, fungi and algae. One of the consequences of antibiotic use is that of antibiotic-associated diarrhea, which can contribute to poor performance in the horse and even mortality. In antimicrobial therapy, the target organism is not the only organism affected by the antimicrobial agent but also the commensal microbiota too (the normal flora of the equine gut). Antibiotics can promote fungal infections and resistant organisms and impede or even eliminate the more sensitive organisms; and they can have both short- and long-term consequences on the gut microbiota composition and function.
Research has indicated that antibiotic treatment may adversely affect metabolic function in the gut by decreasing protein expression responsible for biochemical pathways such as glycolysis, iron uptake, glutamate hydrolysis and possibly even more metabolic functions. The use of antimicrobial drugs directly impacts and possibly contributes to the most notable effect on the gut microbiota of the host, leading to gut dysbiosis; and certain antibiotics can have further-reaching consequences on the microbiota than others. The type of antibiotic and mode of action (bacteriostatic versus bactericidal) will differ in their influences on the gut microbiota composition, e.g., clindamycin operates a bacteriostatic mode of action by inhibiting protein synthesis and exerts a larger impact on the gut microbiota compared to other antimicrobials.
These influential consequences that are imparted by the antimicrobial agent are relatively yet to be elucidated and may result in the manifestation of illness or conditions later in life. For example, the development of asthma in humans has been linked to antibiotic treatment in early childhood as a result of bacterial infections. If researchers were to examine the gut microbiome of horses suffering from chronic obstructive pulmonary disease (COPD) and other chronic respiratory illnesses, it may yield interesting results and establish if there is indeed a link with antibiotic therapy used in horses from an early age.
In comparison to the vast wealth of human studies conducted so far, the volume of equine studies falls disappointingly far behind, but that is changing as researchers focus their interest on developing and filling this gap of knowledge. One such study, which examined the effect of antibiotic use on the equine gastrointestinal tract, demonstrated a significant reduction in culturable cellulolytic bacteria (>99%) from equine feces during the administration period of trimethoprim sulfadiazine and ceftiofur in a study comparing responses to antibiotic challenge. That reduction was still evident at the end of the withdrawal period when compared to the control group. In other words, there was a significant reduction in the ‘normal’ bacteria of the gut. The ability of antibiotics to modulate the gut microbiota was evidenced by the proliferation of pathogenic Salmonella and Clostridia difficile (commonly associated with diarrhea in horses) in the antibiotic challenged horses. This trend of reduction in cellulolytic bacteria associated with antibiotic use was also mirrored in a relatively recent study conducted in 2019, where a short-term reduction in culturable cellulolytic bacteria was combined with a progressive increase in amylolytic bacteria. The heavy reliance on cellulolytic bacteria in the role of equine digestion (without these types of bacteria the horse cannot break down their food) may, therefore, adversely affect the dietary energy available from forage during antimicrobial therapy and may therefore impact performance.
LEFT & ABOVE: If researchers were to examine the gut microbiome of horses suffering from chronic obstructive pulmonary disease (COPD) and other chronic respiratory illnesses, it may yield interesting results and establish if there is indeed a link with antibiotic therapy used in horses from an early age.
Another study that compared the effect of penicillin, ceftiofur and trimethoprim sulfadiazine (TMS) on the gut microbiota in horses using next-generation sequencing showed that TMS had the most profound impact on the microbiota, in particular the phylum verrucomicrobia. This same study also reported a significant decrease in bacterial richness and diversity of the fecal microbiota. A reduction in bacterial diversity is certainly a trend that is commonly seen in gastrointestinal disease in horses. The restoration of the normal gut microbiota after completion of antibiotic treatment can take up to 40 days, but the organizational structure of the bacterial populations can take many years to re-establish the original structure map that was laid out in treating the pre-antibiotic gut.


Equine studies certainly show similarities to human studies, indicating the consequences of antibiotics that can be seen across more than one species. Human studies have reported long-term consequences of antibiotic treatment on the human microbiota. One such human study investigated a seven-day clindamycin treatment and monitored the patients for two years. The impact on the human microbiota remained evident two years posttreatment, where a reduction in bacterial diversity and detection of high-resistance to clindamycin were detected.
Interestingly, no resistant clones were detected in the control group over the two-year sampling period. Another study focusing on the effects of antibiotic treatment for Helicobacter pylori showed findings mirrored in similar studies of that field. The findings demonstrated the rapidly reducing bacterial diversity (one week) after antibiotic treatment and found that disturbances in the microbiota and high levels of macrolide resistance were evident four years post-treatment. Human studies may predict that equine studies will find similar trends with equine antimicrobial therapy. These studies highlight the impact of antibiotic use and the long-term persistence of antibiotic resistance remaining in the intestinal microbiome, which is a concern for both humans and animals.
Innovative Science. Proven Results.
Innovative Science. Proven Results.
the Horse!
EquiOtic™ Foal and Mare
the


Designed to support a mare’s digestive health during pregnancy while helping her foal start life on the right hoof, too!
EquiOtic™ Foal and Mare


Designed to support a mare’s digestive health during pregnancy while helping her foal start life on the right hoof, too!
• Supports gut health in both mares and foals.


Designed to support a mare’s digestive health during pregnancy while helping her foal start life on the right hoof, too!



• Each dose contains 3.75 billion CFU of lactobacillus reuteri and 5 billion CFU of saccharomyces bacteria.

• Administer to mare during the last 30 days gestation to transfer good bacteria to foal.


• Supports immune system development.

• Reduces costs associated with treating diarrhea in foals.




• Easy to administer liquid probiotic.



• Supports development of a healthy immune system and healthy gut in foals.
Supports development of a healthy immune system and healthy gut in foals.


• Supports development of a healthy immune system and healthy gut in foals.
• Delivers20 billion CFU saccharomyces cervisiae and 20 billion CFU lactobacillus reuteri per dose
• Supports development of a healthy immune system and healthy gut in foals.
Delivers20 billion CFU saccharomyces cervisiae and 20 billion CFU lactobacillus reuteri per dose



• Delivers 20 billion CFU saccharomyces cervisiae and 20 billion CFU lactobacillus reuteri per dose.
• Delivers20 billion CFU saccharomyces cervisiae and 20 billion CFU lactobacillus reuteri per dose




• Contains specialized egg proteins that act as antibodies. These antibodies have been specifically produced to guard against gastrointestinal pathogens in the foal.
• Contains specialized egg proteins that act as antibodies. These antibodies have been specifically produced to guard against gastrointestinal pathogens in the foal.
• Contains specialized egg proteins that act as antibodies. These antibodies have been specifically produced to guard against gastrointestinal pathogens in the foal.
• Contains specialized egg proteins that act as antibodies. These antibodies have been specifically produced to guard against gastrointestinal pathogens in the foal.



Antibiotics can lead to the selectivity and proliferation of resistant bacteria, which is evidenced by the long-term effects observed on the gut microbiota harboring drug-resistant encoded genes. Horizontal gene transfer (HGT) commonly occurs in the gut (can be up to 25 times more likely to occur in the gut than in other environments). HGT can be attributed to the close proximity of the microbiota in the gut, allowing the transfer of genetic material via routes such as plasmids and conjugation; in other words, the bacteria in the gut have developed a pathway to transfer antibioticresistant genes from one generation to another. Resistance to antibiotics is now a global issue for the treatment of many diseases. With the unfavorable association tied to Clostridium difficile infections (CDI) and the onset of colitis, particularly in mature horses treated with β-lactam antibiotics (commonly used for equine infections), the incidences in which antimicrobial therapy is considered should be minimized and only used if entirely necessary. The use of broad-spectrum antibiotics in recurrent presentations of symptoms of disease such as urinary tract infections in humans or diarrhea as a result of CDI in both humans and horses is promoting drug resistance. The antibiotics, by disrupting the gut microbiota (which act as a defense against the establishment and proliferation of such pathogenic bacteria) are allowing the opportunity of growth for these multi-resistant microorganisms such as C. difficile, vancomycin-resistant enterococci (VRE), and multi-resistant Staphylococcus aureus (MRSA). The organism

C. difficile and its antibiotic resistance has been demonstrated in the treatment of CDI for both humans and animals. The introduction of vancomycin (a glycopeptide antibiotic) in 1959 for the control of CDI remained effective until the 1990s when a more virulent form of C. difficile emerged. This new form of C. difficile with reported broad-spectrum antibiotic resistance resulted in chronic conditions and increased human mortality.
C. difficile is most noted with human hospital-acquired infections. C. difficile BI/NAP1/027 has been shown to have resistance to fluoroquinolone antibiotics, moxifloxacin and gatifloxacin, which was not seen in historical genotypes. As C. difficile infections are found to cause gastrointestinal disease in horses as well as humans, this is certainly of concern.
Alternative therapies to antibiotic therapy to restore or modulate the gut microbiome after a gut dysbiosis event could be considered in certain circumstances where antibiotics are no longer effective (e.g., CDI), if they’re not the best course (presence of extended-spectrum -β-lactamase (ESBL) producing organisms) or if they’re not essential for example, when the diagnosis of the bacterial cause is uncertain. The rationale to using probiotic treatment along with antimicrobial treatment is that the antibiotic will target the pathogenic bacteria (e.g., C. difficile) and also the commensal microbiota of the gut, but the probiotic bacteria will help to re-establish the intestinal microbiota, and in turn, prevent the re-growth of the pathogenic bacteria in the case or residual spores of C. difficile surviving the antibiotic treatment. Alternative therapies such as fecal microbiota transplant (FMT) or probiotic solutions can reduce the risk of proliferation of antibiotic-resistant bacteria and also have fewer implications on the gut microbiome as evidenced by antibiotic use.
Probiotics have been defined by the Food and Agricultural Organization (FAO) and the World Health Organization (WHO) as “live non-pathogenic microorganisms that, when administered in adequate amounts, confer a health benefit on the host.” The word probiotic is Greek in origin, meaning, “for life”; and the term was coined by Ferdinand Vergin in 1954. While the mechanisms of action of probiotics are complex and require a deeper knowledge of the modulations of the gastrointestinal microbiota, and the health benefits due to their use are the subject of some debate, there is no doubt that probiotics are considered by many as a vital resource to human and animal health.


The use of probiotics in animal production, particularly in intensive swine and poultry production, has increased in recent years, primarily as an alternative to the use of antimicrobials in the prevention of disease. The problem of antibiotic resistance and antimicrobial residues in food-producing animals (the horse is considered a food-producing animal), as a result of historical antibiotic use with the corresponding reduction in antibiotic efficacy in humans, leads to having to look at more sustainable options, such as probiotic use, to combat disease. Probiotics in horses are predominantly used as a treatment modality in the gastrointestinal microbial populations to combat illnesses such as diarrhea—to prevent diarrhea (particularly in foals) or help improve digestibility. Shifts or fluctuations in the microbial populations of the equine gastrointestinal tract have been associated with diseases such as laminitis and colic.
Gut dysbiosis, as mentioned previously, is a fluctuation or disturbance in the population of microorganisms of the gut. It is now being recognized as a cause of a wide range of gastrointestinal diseases; and in horses, it is one of the leading causes of mortality. The ability of probiotics in conferring health benefits to the host can occur via several different mechanisms: 1) inhibiting pathogen colonization in the gut by producing antimicrobial metabolites or by competitive exclusion by adhering to the intestinal mucosa, preventing pathogenic bacteria attachment by improving the function and structure; 2) protecting or restabilizing the commensal gut microbiota; 3) protecting the intestinal epithelial barrier; 4) inducing an immune response.
It is known that there are a wealth of factors that will adversely affect the gut microbiome: antibiotics, disease, diet, stress, age and environment are some of these compounding contributors. To mirror one researcher’s words, echoing from an era where antibiotics were used as growth promoters in the animal industry, “The use of probiotic supplements seeks to repair these deficiencies. It is, therefore, not creating anything that would not be present under natural conditions, but it is merely restoring the flora to its full protective capacity.” In the case of using concurrent antibiotic
and probiotic treatment, this strategic tweaking of the microbiota could be used as a tool to prevent further disease consequences and perhaps help improve performance in the horse.

The benefits of probiotic use in horses have not been investigated extensively, but as mentioned previously, they are now being focused upon by researchers in the equine field. The most common bacterial strains used in equine probiotic products are Lactobacillus, Bifidobacterium, Streptococcus, Enterococcus, Bacillus and yeast strains of Saccharomyces Lactobacillus, Bifidobacterium and Enterococcus strains typically account for less than 1% of the microbiota’s large gastrointestinal populations. Regulation is lacking regarding labeling of probiotic products, often not displaying content with clarification and quality control (such as confirmed viability of strain[s]) not excised with overthe-counter probiotic products. There is evidence to suggest that host-adapted strains of bacteria and fungi enjoy a fitness advantage in the gut of humans and animals. Therefore, there may be an advantage in using the individual animal’s own bacteria as potential probiotics. Probiotics and antibiotics used concurrently could be the way to minimize the introduction of antibiotic-resistant bacterial strains in the gut, and in turn, protect future antibiotic efficacy.

The New York Thoroughbred Breeding & Development Fund, founded in 1973, administers an award program for breeders and owners of NY-bred and NY-sired horses that remains unsurpassed.

NY-sired: Breeder awards up to $40,000 per r ace • Open-company owner awards up to $20,000 per r ace
Non-NY-sired: Breeder awards up to $20,000 per r ace • Open-company owner awards up to $20,000 per r ace
The added incentive of more than 800 races, including more than 60 stakes races, exclusively for NY-breds is another reason why more Kentucky-sired Thoroughbreds are foaled in New York than anywhere outside the Bluegrass State.
JOCKEYCLUB COM 2023
For more information, visit our website or call 518.388.0174
PHOTO OF SONG HILL FARM IN SARATOGA COUNTY BY ANDI DANGELISach organization benefited from strong leadership in its early days. Dr. Dominick DeLuke, an oral and maxillofacial surgeon in Schenectady, New York, became the first president of the New York Thoroughbred Breeders Inc. DeLuke was seldom in the spotlight while he did the grunt work of getting New Yorkbreds more competitive.
E.P. Taylor, the co-founder of the Jockey Club of Canada, was a legendary figure in Thoroughbred racing who is most remembered for his immortal racehorse and sire Northern Dancer. Taylor was seldom out of the spotlight. Asked of E.P. Taylor’s impact, Jockey Club of Canada Chief Steward Glenn Sikura said, “How would I do that? I think the word that comes to mind is visionary. Would we have Woodbine racetrack without E.P. Taylor? Absolutely not.”
How do you start improving a breeding program? You begin with incentives. Using a small percentage of handle on Thoroughbred racing in New York State and a small percentage of video lottery terminal revenue from Resorts World Casino NY at Aqueduct and at Finger Lakes, the New York State Thoroughbred Breeding and Development Fund Corporation rewards owners and breeders of registered New York-breds awards for finishing in the top four in a race and provides substantial purse money for races restricted to New York-breds. The Fund pays out $17 million annually in breeder, owner and stallion owners awards and in purse enrichment at New York’s tracks.
“If it wasn’t for the rewards program, I wouldn’t be in the business,” Dr. Jerry Bilinski of Waldorf Farm said. “The program is the best in the country in my view and it helps the vendors, feed stores and all that.”
Bilinski, the former chairman of the New York State Racing and Wagering Board, bred his first New York-bred mare, Sad Waltz, in 1974.
He acknowledges DeLuke’s vital contribution. “Dr. DeLuke was a forefather,” Bilinski said. “I had dinner with him a number of times. He was smart. He was a smart guy. He didn’t try to reinvent the wheel.”




Instead, DeLuke, a 1941 graduate of Vanderbilt University and the Columbia University School of Dental and Oral Surgery, began breeding horses before the New York-bred program even began. He humbly visited every Kentucky farm that would receive him and asked dozens of questions about everything from breeding practices to barn construction to fencing. He learned enough to own and breed several of the fledgling New York-bred stakes winners. Divine Royalty, Vandy Sue, Dedicated Rullah and Restrainor won four runnings of the New York Futurity for twoyear-olds in six years from 1974 through 1979. Restrainor also was the winner of the inaugural Damon Runyon Stakes in 1979.
DeLuke purchased a 300-acre farm in the foothill of the Adirondacks and named it Assunta Louis for his parents. Two decades later, Chester and Mary Bromans, the dominant owners of current New York-breds, many of whom have won open stakes, purchased the farm in 1995 and renamed it Chestertown. They named one of their New York-bred yearlings Chestertown, and he sold for a record $2 million as a two-year-old.
Long before that, the New York-bred program needed a spark, and a valiant six-year-old gelding named Fio Rito provided a huge one in 1981. Fio Rito was literally a gray giant, 17.1 hands
The New York State Thoroughbred Breeding and Development Fund Corporation and the Jockey Club of Canada are celebrating their golden anniversaries in 2023, and both are as vibrant and vital as they have ever been.
and 1,300 pounds. Twenty-two years before Funny Cide won the Kentucky Derby and Preakness Stakes, Fio Rito, who was owned by Ray LeCesse, a bowling alley owner in Rochester, and trained by Mike Ferraro, who is still going strongly at the age of 83, Fio Rito put his love of Saratoga Race Course to the test in the Gr.1 Whitney Handicap. A legend at Finger Lakes, where he won 19 of 27 starts, he had posted four victories and a second in five prior Saratoga starts.
He almost didn’t make the Whitney. Two days before the race, Fio Rito, who had won his four prior starts, injured his left front foot. It wasn’t serious. But the competition was. Even though there had been three significant scratches—Temperence Hill, Glorious Song and Amber Pass—he was taking on Winter’s Tale, Noble Nashua and Ring of Light.
Ridden by Finger Lakes superstar Les Hulet, Fio Rito broke through the starting gate before the start, usually a recipe for disaster. But assistant starter Jim Tsitsiragos, held on to Fio Rito’s reins and didn’t let Fio Rito get away.

Though pushed on the lead every step of the way, Fio Rito held off Winter’s Tale to win by a neck in 1:48, just one second off Tri Jet’s track record and the fourth fastest in the Whitney’s illustrious history.
“TV and the media made sort of a big deal for a horse to come from Finger Lakes and be a New York-bred too,” Ferraro said. “It was kind of exciting for us to even compete in that race.”
The following year, another New York-bred, Cupecoy’s Joy, won the Gr.1 Mother Goose Stakes.

Still, New York-breds had a long way to go to be really competitive against top open company.
In 1992, Saratoga Dew won the Gr.1 Beldame and became the first New York-bred to win an Eclipse Award as Three-Year-Old Filly Champion.


Two years later, Fourstardave completed a feat which may never be approached let alone topped. He won a race at Saratoga for the eighth straight year. Think about that. It’s the safest record in all of sports. Three years earlier, Fourstardave’s full brother, Fourstars Allstar, won the Irish Two Thousand Guineas.
And then came Funny Cide with Jack Knowlton and Sackatoga Stable, trainer Barclay Tagg, Hall of Fame jockey Jose Santos and a yellow school bus. Funny Cide was born at Joe and Anne McMahon’s farm, McMahon of Saratoga Thoroughbreds.

The McMahons, 76-year-old Joe and 73-year-old Anne, have been breeding, raising and racing horses before the New York-bred program started. They now boast a 400-acre farm with some 300 horses including 70 of their mares, 70 other mares, stallions including their star Central Banker, yearlings and foals.
“We’re very proud of what we accomplished,” Joe McMahon said. “It feels very good. It’s something we focused on for 50 years. With all the farms that have come and gone, it’s amazing that we’re still here.”
Now they have their three children helping run the business. They had nobody when they started. A wedding present from
Fio Rito winning the 1981 Whitney Handicap. ABOVE: In 1992, Saratoga Dew became the first New York-bred horse to win an Eclipse Award. Joe McMahon and a yearling. Anne McMahon and Classical Ballet.Slowly, the New York-bred program created interest. The McMahons did everything they could to help, successfully lobbying for changing the residency rules for mares in New York and beginning the New York-bred Preferred Sales. “I recruited the horses for the New York-bred sales,” McMahon said. “I’m very proud of that because that changed the whole business. It created a market. It was the early ‘90s. That was a real-game changer, and it is today.”
Today, the McMahons stand Central Banker, the leading stakes sire outside of Kentucky. “We went from breeding $1,000 stallions in New York to standing the best horse out of Kentucky,” McMahon said. “That’s a huge thing. He and Freud are the most successful stallions in New York.”
He continued, “We should be the poster child for the breeding program because we didn’t have anything starting out. Everything we got, we literally put back in the game. We continue to operate. I thought that was the purpose of the program: to maintain agricultural land that otherwise would have been developed commercially.”

Funny Cide was a turning point. “Funny Cide was a real gamechanger for the whole industry,” McMahon said. “It was like an impossible dream come true. It was remarkable that a New Yorkbred won the Kentucky Derby.”

It was also remarkable what his jockey said after winning the race. At the time of the 2003 Kentucky Derby, there had been a popular television commercial sponsored by the New York Thoroughbred Breeders, Inc., trumpeting the rich award program of New York State. After Funny Cide won the 2003 Kentucky Derby, commentator Donna Barton on horseback was the first person to interview Santos. She said, “You’re very happy about winning the Derby.” Jose replied with the catchline of the TV Commercial, “Get with the program, New York-breds.” Years later, Santos said, “I don’t even know how it came out of me. That surprised me when I heard it.”
Funny Cide added the 2003 Gr.1 Preakness Stakes and the 2004 Gr.1 Jockey Club Gold Cup.

A steady stream of accomplished New York-breds, including 2006 Gr.1 Beldame Stakes winner Fleet Indian and two-time Gr.1 Whitney winner Commentator (in 2005 and 2008) followed, before New York-breds provided more jolts. Mind Your Biscuits, the all-time leading New York-bred earner ($4,279,566), captured the 2018 Gr.1 Golden Shaheen in Dubai. That summer, Diversify added his name to the list of Whitney winners.
In 2019, Sackatoga Stable and Barclay Tagg’s Tiz the Law began his sensational two-year career by winning his debut at Saratoga. He added the Gr.1 Champagne, then dominated in both the 2020 Gr.1 Belmont Stakes—the first leg in the revised Triple Crown because of Covid—and the Gr.1 Travers Stakes. He was then a game second to Authentic in the Gr.1 Kentucky Derby.

“When people buy a New York-bred, they hope he can be the next Funny Cide or Tiz the Law,” Fund Executive Director Tracy Egan said. “I think it’s the best program in the country.”
That doesn’t mean it’s been a smooth journey. “It’s been a bumpy road,” former New York Racing Association CEO and long-time New York owner and breeder Barry Schwartz said. “There were so many changes. But I think today they’re on a very good path. I think the guy they have in there (New York Thoroughbred Breeders Inc. Executive Director Najja Thompson) is pretty good. Clearly, it’s the best breeding program in America.”
The 2023 Canadian Premier Yearling Sale is the best place to sell your Ontario bred yearling.








Thompson said, “The program rose from humble beginnings to today when we see New York-breds compete at the highest level.”
Certainly the New York Racing Association supports the New Yorkbred program. One Showcase Day of all New York-bred stakes races has grown into three annually. “NYRA has been a great partner in showcasing New York-breds,” Thompson said. “We make up 35 percent of all the races at NYRA.”
There’s a great indication of how New York-breds are perceived around the world. Both the third and fifth highest New York-bred earners, A Shin Forward ($3,416,216) and Moanin ($2,875,508) raced exclusively in Asia. A Shin Forward made 25 of 26 career starts in Japan—the other when he was fourth in a 2010 Gr.1 stakes in Hong Kong. Moanin made 23 of his 24 starts in Japan and one in Korea, a 2018 Gr.1 stakes.

This year, new stallion Mind Control, who won more than $2.1 million, brought together three New York farms together: Rockridge Stud, where Mind Control stands, Irish Hill and Dutchess Views Stallions. Mind Control’s strong stallion fee of $8,500 certainly reflects confidence in the New York-bred program.
“If you look at the quality of New York-bred horses, it just proves that it’s a success,” Bilinski said. “We’re never going to be Kentucky, but we’ll



Jockey Club came to life on Oct. 23, 1973, and its board of stewards were announced Oct. 27.

The very next day, the entire racing world was focused on Canada, specifically at Woodbine, where 1973 Triple Crown Champion Secretariat made the final start of his two-year career. Racing under Eddie Maple—a lastsecond replacement when jockey Ron Turcotte chose not to delay a suspension in New York, costing him the mount—Secretariat aired by 6 ½ lengths in the Canadian International as the 1-5 favorite.
At its initial meeting, Taylor was elected the Jockey Club’s Chairman of the Board and Chief Steward. The other eight founders were Colonel, Charles “Bud” Baker, George Hendrie, Richard A.N. Bonnycastle, George Frostad, C.J. “Jack” Jackson and J.E. Frowde Seagram.
“These people were all very successful at what they did,” Jim Bannon, a Thoroughbred commentator who is in the Canadian Hall of Fame, said. “They were great business people who had a great sense of adventure and got in early when it was time for the Jockey Club. They were all gung-ho to be there. I think we got the best of the best right at the beginning.
member of the United States Jockey Club in 1953 and also the first Canadian to be elected president of the Thoroughbred Racing Association in 1964. In 1973, he was named North America’s Man of the Year. He won Two Eclipse Championships as Outstanding Breeder in 1977 and 1983.
Of course, by then, Northern Dancer’s brilliance on and off the track had been well documented. On the track, Northern Dancer won 14 of 18 starts, including the Gr.1 Kentucky Derby and Preakness Stakes, with two seconds and a pair of thirds including his six-length defeat by Quadrangle in the 1964 Belmont Stakes. Northern Dancer more than atoned in his following start, winning the Queen’s Plate by 7 ¼ lengths as the 1-10 favorite. Taylor won the Queen’s Plate 11 times under his own name or Windfields Farm and bred 22 winners of Canada’s signature stakes. But Northern Dancer bowed a tendon shortly after winning the 1964 Queen’s Plate and was retired.
Initially, Northern Dancer’s stud fee at Windfields Farm in Maryland was $10,000. That changed quickly in 1967 when his first seven sales yearlings all won. Five of them won stakes. Northern Dancer’s stud fee was up to $100,000 in 1980 and climbed to $200,000 just two years later.
Northern Dancer sired 146 stakes winners, including several who went on to be great stallions themselves including Lyphard, Nijinsky II, Nureyev, Danzig, The Minstrel, Sadler’s Wells, Storm Bird, Vice Regent and Be My Guest. “Of all my father’s accomplishments in racing and breeding, I believe he was most proud of having established the Northern Dancer sire line,” Taylor’s son, Charles, said in the book Champions.

Taylor’s impact on Canadian racing can’t be overstated. He consolidated Canada’s seven tracks to three, improving Fort Erie
and Old Woodbine/Greenwood and building a new Woodbine. “Without Mr. Taylor, Canadian racing would not be!” Hall of Fame trainer Frank Merrill said.
In 1973, Taylor resigned as the Chairman of the Ontario Jockey Club to head the Jockey Club of Canada. “We’ve never had a national Jockey Club before,” Taylor said at the time. “We felt it was important to Canadian racing to have this kind of organization, which could address important racing issues of the day.”
Fifty years later, the Jockey Club is still leading Canadian racing. Its current membership tops 100 with owners, breeders, trainers and key industry stakeholders.
Among its duties are conducting the annual Sovereign Awards; annually designating graded stakes; working to improve federal tax guidelines for owners and representing Canada at the annual International Federation of Horse Racing Authorities Conference.

“There are a lot of running parts,” trainer and Jockey Club member Kevin Attard said. “It kind of opens your eyes to a different part of racing from a trainer’s perspective. There’s a lot of things that go on a daily basis to have the product we have and put on the best show possible.”
Hall of Fame trainer Mark Casse, also a member of the Jockey Club, said, “It’s a great organization. It’s always trying to do what’s best for horse racing.”
That means continuing the battle for tax relief. “This is something that is extremely important to the Canadian horse owners and breeders,” Casse said. “It’s definitely the number-one priority.”
Sikura, who is also the owner of Hill ‘n’ Dale Farm Canada, said, “Fighting to get tax equity has been a battle for decades. We haven’t made major strides, but that won’t mean we stop trying. It doesn’t compare favorably to other businesses.’’
Asked about progress on that issue, he said, “We’re marginally better off.” In general, Sikura said, “I think we have the same challenges most jurisdictions have. I’m cautiously optimistic. It’s always been an uphill battle, but horse racing people are a resilient group.”
Recent history reveals the importance of biosecurity on both the racetrack and also Thoroughbred breeding farms. In 2021, a life-threatening Rotavirus B outbreak in foals swept through farms in Central Kentucky, taxing farm staff and management with contagion containment.


More recently, in 2022, an outbreak of equine Herpesvirus-1 at Churchill Downs resulted in a quarantine of as many as 13 horses in one barn. Contagiousness of this EHV-1 meant horses even indirectly exposed to horses with the virus were also quarantined in two other barns.
EVH-1 isa far more serious threat in that more horses risk exposure on racetracks than on a farm. The virus causes respiratory disease, neonatal death, and neurologic disease, EHM

(equine herpesvirus myeloencephalopathy). EHM is often fatal and if not, can leave long-term problems. Symptoms presenting EHM are heart-rending: Horses will lack coordination, have weakness or paralysis in some or all of their limbs, and become unable to balance or stand.
Contact and contagion are the dangers to horse health with viruses like EHV-1 or rotavirus B. Horses travel, and Kentucky might be the busiest crossroad in the world with Thoroughbreds coming in from all points in the country and world and traveling out to racetracks out-of-state and, of course, foreign countries. Experts agree that every effort has to be made in this state and elsewhere with biosecurity to prevent repeats of what happened last year and in 2021. They also are in agreement that trainers are the first line of defense.
Cleanliness, or biosecurity, is essential to horse health and is at the core of minimizing infectious disease outbreaks and subsequent quarantines. Failures in biosecurity can mean canceled race days; idle trainers; and most important and awful, dead or injured horses.Eclipse Sportswire, GaloppFoto.de, Laura Palazzolo, Equine Bio Genie
Because they see and care for horses daily, trainers will be the first to note abnormalities or symptoms of disease, according to Dr. Stuart Brown, vice president of equine safety at Keeneland Race Course.
“Trainers are the sentinels, the keepers of horse health, them and their attending veterinarians,” he said. “They’re at the forefront of working with regulatory veterinarians as well as the state veterinary offices to maintain a healthy population of horses.”

The consensus among industry people like Brown is that trainers, with only a small minority of exceptions, do an excellent job because so much is at stake.
“By and large, they’re all very attuned to disease transmission,” echoed Dr. Will Farmer, equine medical director for Churchill Downs and all other racing properties.

They have to be, he added. “If a trainer has a sick horse, a groom is taking care of it and multiple horses. There’s the possibility of spreading a disease. Trainers are very keen on biosecurity.“
Trainers, especially, must be sensitive to biosecurity in their barns as they move their stable from one race meet to another and new stalls for their horses.
“I’ve shipped everywhere—Gulfstream, Tampa, New York a lot, Laurel a lot,” said Ian Wilson, assistant trainer to Graham Motion, naming only a few of the destinations for horses at the Fair Hill Training Center in Maryland.
He’s encountered conditions he described as “generally good.”
“You never walk into a stall and say, ‘This one needs another bag of shavings or another bale of straw.’
“Where our concern lies is what you don’t know. A clean stall and a dirty stall sometimes don’t look that different.”
Receiving barns, which especially should be as pathogenfree as possible, is not guaranteed. “In New York, I know the gentleman who takes care of the receiving barn and he does a really, really, nice job of it. I’ve watched him clean a stall, and he does it properly. In other places, I’ve seen them pick over a stall really quickly, and off they go.”
While disease outbreaks are sporadic, the goal, of course, is minimizing the maximum potential for occurrences. A mantra for Brown at Keeneland is “the solution to pollution is dilution.” In other words, every resource—human and inanimate—should be brought to bear to combat the potential for disease development, particularly with the cleaning and disinfecting of stalls. Every measure, however, will only dilute or reduce issues that arise.
While receiving barns will have straw down and should be clean, standard operating procedure for trainers moving horses from a barn they’ve occupied to another location and unfamiliar stalls is cleaning and disinfecting before another horse can move in. Stalls are mucked daily and cleaned, but disinfecting is a must. Frequency, though, varies among trainers; some might disinfect weekly, others only monthly.
At Keeneland, the maintenance team follows departed trainers and does a second disinfecting to ensure the next occupant gets a clean environment. “Our team will go in,



and they’ll basically strip and clean (disinfect) all of the stalls,” said Brown. “They’ll be left for a period of time for desiccation (allowing stalls to dry out). Getting those stalls tossed out and then having them air out and dry as well as being inspected becomes a part of any kind of biosecurity protocol.“
Trainers, with few exceptions, follow guidelines prescribed by the Equine Disease Communication Center to one degree or another. These include scrubbing surfaces with warm, soapy water to remove any traces of organic matter (basically anything that comes out of a horse); allowing the surface to dry; applying a disinfectant; allowing the surface to dry after the application of a disinfectant; and disinfecting crossties if in use.
The choice of disinfectant is at the discretion of a trainer or attending veterinarian. Brown said his maintenance team uses products recommended by the USDA or other regulatory bodies that are specified for controlling the spread of potentially infectious pathogens.
He is investigating a new “delivery system” of a disinfectant from a firm in Nicholasville, Ky., just south of Lexington, produced by Atmosphere Supply. The firm supplies a foaming product for farms of all types that have applications (literally) for racetrack stalls.
Peter Healy, business development manager for the firm, authored a manual, titled Biosecurity for the Equine Industry, after Thoroughbred farm personnel sought help during the rotavirus B epidemic. Healy’s company was asked to assess and critique biosecurity protocols and other practices. “Everybody was in a panic with this new rotavirus back in 2020,” he said.

One key recommendation right off the bat from Healy was to not use bleach. “It is for hard (non-porous) surfaces, not for wood. It does absolutely nothing when applied to wood and could possibly be harmful to a horse.”
Other disinfectants like hydrogen peroxide have the potential to be caustic or acidic and also hazardous. “Horses rubbing against a stall wall are going to come in contact with whatever has been applied,” Healy said.





One particular issue is the application of a disinfectant. Wiping down or spraying with a liquid in a dark stall means the possibility that coverage might be incomplete. A liquid will also run off quickly, according to Healy. The foam disinfectant produced by his company solves both problems and dries in only 10 minutes. Use or frequency of use is at a trainer’s discretion, but it could be applied daily.
Healy also recommends any product containing hypochlorous acid, primarily a salt and water mixture, that can be sprayed daily even while a horse is in the stall, as ingestion will not harm them.
Other measures to battle pathogens or disease-producing agents are largely a matter of common-sense hygiene. Water buckets at the end of a shedrow that every horse passing by can drink from are asking for disease to spread.


“Equipment contacting a horse can also be a source for contamination,” said Brown. “I know two or three trainers that have started dipping chains and shank clips in a water-diluted Nolvasan solution.” Nolvasan is a readily available skin and wound cleanser. It helps prevent disease spread if a hotwalker is going from horse to horse with the same shank, according to Brown.
Pathogens are generally organic but can be carried by humans. Here, too, there are preventive measures. Farmer at Churchill Downs noted that some trainers there are having their help wear gloves at feed time as they mix feed and add supplements. “That’s a proactive approach. They recognize they don’t have control over barn help 24/7,” he said.
Is there a day when grooms and hotwalkers are wearing gloves all the time, or stalls with a “last disinfected” sheet with dates posted on each? All who were questioned for this story can’t see it, but similar and more stringent measures are already in place in Europe. At some racetracks in France, each stall will have a plastic seal that someone must break to enter—a guarantee that a stall has been disinfected.
Over there, stall bedding and cleaning are the responsibility of the racetrack generally as most horses are day shippers. Some trainers have traced ringworm to sanitizing agents used by racecourses. “We are not told what they are using; there’s no real regime. Biosecurity is everything; it’s so important,” said French trainer Ilka Gansera-Leveque.
Gloves, plastic seals, “last disinfected” sheets… Sound far-fetched for American racetracks? Who knows? But if the solution to pollution is dilution…




Six days before St. Patrick’s Day, the four Irish partners of Hunter Valley Farm near Keeneland found their elusive pot of gold, not at the end of the rainbow, but in the final 10 yards of the Gr.1 Beholder Stakes. That’s where their filly A Mo Reay thrust her nose past odds-on favorite Fun to Dream, giving the Irish quartet their first Gr.1 stakes victory at Santa Anita; half a world away from the Irish National Stud in Kildare, where two of the four, Adrian Regan and Fergus Galvin, met in 1991.

“It was a surreal day,” Regan said. “When we set up the farm, the thought of having a Gr.1 was never even thought about. We were hoping to make the farm viable. We’ve been very lucky. Without my partners, it never would have happened for sure.”
Asked if he could ever have imagined such a feat when he was a younger lad in Ireland, Adrian’s buddy Galvin said, “It was nowhere near the front of my mind.”
Certainly, their two somewhat silent partners, Tony Hegarty and John Wade, had no idea. Those two friends met in a tavern in Chicago, then became business partners, founding A & J Construction, a successful construction company in Lockport, Illinois, 30 miles southwest of Chicago. Hegarty and Wade started out as carpenter contractors and eventually switched to land developers and custom home builders. “We’re doing okay,” Wade said.
Okay enough to speculate in Thoroughbreds. “It turned out to be an amazing adventure,” Hegarty said. “We’re more or less silent partners. Fergus and Adrian pick the horses.”
They do so adeptly. “Those guys—they come up with some good ones,” Wade said.

Both Galvin and Regan credit their fathers for their equine education.
“It was part of my childhood,” Galvin said. “My father ran a small stud farm in Dublin. I have him to thank for my early grounding and the early education. He had a couple of horses in training. From the age of eight, I was by his side most of the way. I have him to thank for where I am now. He’s doing great—keeps a close eye on the U.S. My dad is 84.”
Galvin said both his parents visit the United States. “They came over last spring to Keeneland,” he said. “They really love Kentucky. There’s no place like Kentucky in the spring. Kentucky is almost my home away from home. In Ireland, everyone has some involvement. There’s a large part of our population who has connections in the horse business. They have a deep love of horses.”
They frequently pass that love on to the next generation, a tradition Galvin and his wife, Kate, who works at Godolphin, will likely instill in their four young children, Marie, 10, Harvey, 8, and twin boys Joseph and Nicholas, 6.

Galvin’s experience at Irish National Stud helped shape his future. The Stud, founded in 1918, annually offers a six-month residential course which begins every January. Its goal is “to equip learners with the knowledge, skills and competence required to perform effectively in responsible positions in the Thoroughbred industry.”
It’s where Regan and Galvin became life-long friends. Regan, too, credits his father: “I wanted to be a trainer like my father T.A. was. When I left school, I went working for him.”
Both Galvin and Regan honed their skills before deciding to buy a farm. “I’ve been lucky enough to have some great employers before we started out,” Galvin said. “First I was at Pin Oak Stud
for five years. Then I ran a small operation, Newgate Farm, and did a six-year stint at Ashford. It was very invaluable to me going forward. That really sent me on the path we are on today.”
Regan spent four years at Langford Farm breaking yearlings. “I loved my time there,” he said. “It gave me a great foundation.”

Providence brought Hegarty and Wade together. “Myself and Tony became friends when we got to this country in March 1981,” Wade said. “I had just come over here in the middle of March. He came around the same time. We hung out together. We were buddies. We started our own construction business.”
Like Galvin and Regan, Wade had a love of horses growing up in Ireland. “I loved them,” he said. “I didn’t have the funds to buy any.”
Then Wade went to Kentucky. He watched Unbridled win the 1990 Kentucky Derby—as his trainer Carl Nafzger called the stretch drive for owner Mrs. Genter—and was hooked. “That’s what probably did it,” Wade said. “I had another Irish friend who would go to Keeneland: Pat Costello. He advised me to take a run out to Lexington to see the farms. I met a bunch of my countrymen. Every now and then, some of them did syndicates. I said, “If you do it again, count me in.” Then I talked my partner, Tony, into getting involved.”

Hegarty didn’t have an early equine education in Ireland. “I’m from northwest Ireland,” he said. “Horse racing is in the other parts of Ireland. Up my way, there was no horse racing. There are no tracks.”

Yet, he was all-in joining his friends to buy and breed Thoroughbreds. Together, the four Irishmen purchased Golden Gate Stud in Versailles in 2004 and renamed it Hunter Valley Farm. In its first year of operation, its first yearling that went to auction was Scat Daddy. All he did was post five wins, including the Gr.1 Florida Derby, in nine starts, earn more than $1.3 million and become the sire of 69 stakes winners, including undefeated Triple Crown Champion Justify before dying at the age of 11. Hunter Valley Farm had sold him as a yearling for $250,000. “Unbelievable to have that quality of horse in our very first year,” Wade said.
In November 2022, the Irishmen bought three-year-old A Mo Ray for $400,000 in the Fasig-Tipton Sale. Trained by Brad Cox, she won a $97,000 stakes at the FairGrounds and the Gr.3 Bayakoa Stakes at Oaklawn Park.



Cox shipped her to Santa Anita to contest the Gr.1 Beholder Stakes March 11. The filly she had to beat was Bob Baffert’s Fun to Dream, who had won four straight and six of her seven lifetime starts. She went off at odds-on, A Mo Reay was the 7-1 third choice in the field of eight.
“It was funny going back to Santa Anita,” Regan said. “I did a short stint with Bob Baffert years ago.”
In deep stretch, Baffert’s favorite was desperately trying to hold off the rallying A Mo Reay and jockey Flavien Prat. They crossed the finish line in tandem.
Hegarty and his wife, Sheila, were watching the race from their home. “We were screaming our heads off,” he said. “You’re screaming at the TV, egging her on, egging her on. I thought she got up.”
She did.
Wade was asked if it occurred to him that the race was six days before St. Patrick’s Day. “It did not,” he said. “But we celebrated like it was St. Patrick’s Day.”






A realistic outlook and a sense of humor are mighty handy tools for breeding and racing Thoroughbreds. John Ropes is blessed with both.
“If you’re in this business to make money, you’re in the wrong business,” Ropes said. “Once you’re infected, you’re hooked. The only way out is bankruptcy.”
Ropes is the head of Ropes Associates, an international executive search firm specializing in real estate development and related financial services in Fort Lauderdale, Florida, established in 1975. He began his Thoroughbred involvement five years later and opened Rosegrove Farm in Ocala in 1985.
He has yet had the misfortune of bankruptcy to get out of the Thoroughbred business, but last year certainly tested his resolve. “We lost seven foals for a variety of reasons,” he said. ”It was extreme bad luck. You just have to put it behind you and keep moving on.”
And then a horse like Dorth Vader changes everything, giving Ropes his first graded stakes victory by taking the Gr.2 Davona Dale Stakes at Gulfstream Park, March 4, earning enough points to get into the Kentucky Oaks. Making the victory even sweeter were her odds: 46-1 in the field of 11. “Frankly, I thought she’d win,” Ropes said. “46-1? That was crazy.”

And fun. “We’ve had some fun in it,” Ropes said. “Horse racing should be fun. It’s an exciting business. I’ve been in it way too long. I love the business. You have to.”
His love of horses traces back to riding horses during a summer spent in England. “I always liked it,” Ropes said. “My parents always went to the track on New Year’s Day every year. But you had to be 21 to get in.”
He would get into racing at a level he could never have envisioned. He bought a riding horse when he was a senior in college, and he thanked a girl who worked for him, Dana Smithers, for getting him into Thoroughbreds. “Her father, Andy Smithers, is a trainer in Canada and in Florida,” Ropes said. “She told her dad I was interested, and Andy, who was then training at Gulfstream Park, found a horse for me. His name was Half French, and he was a $15,000 claimer who hadn’t won a race in a long time. I said, ‘Andy, why are we buying this horse?’ He said, ‘Look at those feet. These are grass feet.’”
Smithers was right.
Shipped to Canada and switched to grass, he won two allowance races and finished fifth in $50,000 stakes. Ropes got an offer for $50,000 for his horse and turned it down. “Then he broke his leg,” Ropes said. Half French returned to the races after a year, but he was never the same horse. And Ropes hadn’t waited for his return before escalating his interest in Thoroughbreds.
Ropes’ burgeoning business, Ropes Associates, allowed him to pursue his passion. Ropes earned his Bachelor of Arts degree at the University of Florida and his Master’s in Business Administration at the University of Miami. He began Ropes Associates in 1975, and he became an important business leader in Fort Lauderdale. He became a governor in the Urban Land Institute, a non-profit research and education organization for real estate developers with offices in Washington, D.C., Hong Kong and London. Ropes served as chairman of the ULI’s Southeast
Florida/Caribbean Real Estate Opportunities Conference held in Miami in 1993 and in Puerto Rico the following two years. He is also a licensed single-engine pilot.
Half French had given him an intriguing taste of Thoroughbred success, and he didn’t wait for his recovery to buy another.
“Half French broke his leg, and I had to buy other horses,” Ropes said. “Some had success, and some had not. I started breeding some fillies, and I knew nothing about breeding. Andy helped me. And then I said, ‘Why don’t I buy a farm?’”
He bought Rosegrove Farm in Ocala in 1985. His timing stunk. “That was just before President Reagan changed the tax laws,” Ropes said. “The market crashed for a horse farm. It was a brutal time. But somehow we lasted through it. Life is about experience.”
Seeking another experience, Ropes began training a few horses and selling horses before deciding to concentrate on breeding. “I bought all my own mares,” Ropes said. “I had mixed success. I had to step up my game. I got an agent, Marette Farrell. We were buying very good broodmares.”
He bought a really good one, Hardcore Candy, a daughter of Yonaguska out of the Thunder Gulch mare It’s a Girl. Hardcore Candy had won eight of 40 starts on the track and earned just over $100,000, Bred to Girvin, Hardcore Candy foaled Dorth Vader. Ropes explained the name: “My significant other for the last six years is named Dorothy Harden. She’s an attorney. She said, 'You name a horse after all your family, but you’ve never named a horse for me.’ She liked Star Wars. We came up with Dorth Vader almost instantly. When I suggested it to her, she was a little shocked, but after a while, she liked it.”
Ropes usually breeds horses for the sales, but he had the good fortune to hold on to Dorth Vader. “Everyone at the farm loved Dorth Vader,” Ropes said. “Gayle Woods said she had a beautiful body, but that she was a little offset in her right front. I knew I wouldn’t get what she was worth at the sales. Gayle was so high on her, and so was everybody else on the farm. Gayle said, ‘She’s more of a runner.’”
She was. Trained by Michael Yates, Dorth Vader won three of her first five starts, including a four-length victory in the Just Secret Stakes for Florida-breds and a 2 ¼-length score in the $100,000 Sandpiper Stakes at Tampa Bay Downs. She then tired badly to finish a distant sixth in a $50,000 stakes at Tampa as the 7-5 favorite.
She was taking a mighty step up in the Gr.2 Davona Dale at Gulfstream Park and went off a huge price under jockey Miguel Vasquez. But she didn’t race like a hopeless longshot, disposing even-money favorite Red Carpet Ready in early stretch and powering away to a 4 ¾ length victory.

She’d given Ropes his first graded stakes. “It was a thrilling experience,” Ropes said. “Of 18,700 foals born, only 14 get into the Kentucky Oaks. She has enough points to make it, so we don’t have to do anything else. Nothing is as thrilling as winning a Gr.1 or a Gr.2 stakes. It’s excitement! It’s why we're in the business. I had never won a graded stakes before. Now I have.

Not selling a pair of two-year-olds turned out to be the best thing to ever happen to Andrew Warren.
Both Raise Cain, the emphatic winner of the Gr.3 Gotham Stakes at Aqueduct, Warren’s first graded stakes victory, and Scoobie Quando, a troubleplagued second in the John Battaglia Memorial Stakes at Turfway Park that same evening, are now live Kentucky Derby contenders off powerful performances hours apart. Earlier this year, Scoobie Quando gave Warren his first stakes victory, taking a $120,000 stakes at Turfway by a neck in his first career start. As if that wasn’t enough, Warren’s Wizard of Westwood finished second in the Baffle Stakes at Santa Anita the day after the Gotham and the Battaglia.
That’s quite a feat for Warren, who followed his dad into the business with the intent to buy one mare in 2019. “It’s amazing,” Warren said. “It’s hard to believe. To be in this position, it’s definitely rare and unusual—kind of a shock.”
A very happy shock for Warren and his wife, Rania and their adorable three-year-old daughter Valentina. “Having a young child at home, she likes it quite a bit,” Warren said. “She likes all animals. She loves to go to the zoo. She loves our two dogs. She likes the excitement of racing.”
She is the next generation of the Warren family, who have a legacy of continuing success in their Tulsa, Oklahoma-based Warren Petroleum Oil Company and a deep love of Thoroughbreds.
“My grandfather got involved very early on,” Warren said. “He started the company. He was sort of a pioneer in the business. He wound up selling it to Gulf Oil.”
William Kelly Warren, who was born in 1897 and lived to 1990, was philanthropic. “He started a hospital—St. Francis,” Andrew said. “Now there’s a second hospital. It’s the largest healthcare system in Eastern Oklahoma. That was something he was passionate about.”
His grandfather also had a passion for horses. “He didn’t own horses, but my grandfather was a fan,” Warren said. “That’s how my dad got interested in it. They had a vacation house in La Jolla. My dad grew up going to Del Mar with his dad. He bought his first horse in 1983.”
Warren’s father William and his mom Suzanne had a slew of top horses, including 2005 Breeders’ Cup Classic winner and 2005 Horse of the Year Saint Liam and City of Light, who captured three Gr.1 stakes, the 2018 Triple Bend, the 2018 Breeders’ Cup Dirt Mile and the 2019 Pegasus World Cup.
Warren’s parents also had two Kentucky Derby starters, Knockadoon, who finished seventh in 1995, and Denis of Cork, who finished third in 2008. “We got to experience those thrills, those highs, as a family,” Andrew said. “I was 13 in 1995. It was a great time to be a kid and go to the Derby.”
He also saw other family horses who didn’t fare as well. “I saw a lot of the industry—a lot of ups and downs,” Warren said. “My takeaway was that it’s very difficult and very hard to do. The odds are not in your favor for success.”

Yet, he was intrigued about the breeding of Thoroughbreds. “I’d been to sales with my father,” Warren said. “I saw horses selling for quite a bit of money. I thought breeding was very interesting. He liked the racing and [was] not too excited about breeding.”
Specifically, he wondered who were the best mares to be bred to City of Light when he retired from racing. “He was getting some interest,” Warren said. “I thought this was intriguing. It’d be fun to breed a mare to him. I asked City of Light’s trainer, Michael McCarthy, what he thought, and said, ‘I think that makes sense.’”
They went to the OBS Sales and perused a list of potential mares. “We watched videos of breezes,” Warren said. “We picked one. Then we picked another. I had a lot of enjoyment of picking out the horses, the analysis of trying to find the right one. I wound up getting a colt. In 2019, I went through every sales catalog. I bought two mares in foal to City of Light. I went further down the rabbit hole.”
He had no idea. He currently has 23 horses racing.
At the 2021 Keeneland September Yearling Sale, Warren purchased Raise Cain, a son of Violence out of Lemon Belle by Lemon Drop Kid, for $180,000, and Scoobie Quando, a colt by Uncle Mo, for $160,000.
Warren tried pinhooking both, but Raise Cain went through the sales ring unsold for $65,000, and Scoobie Quando failed to reach his reserve at $125,000. “I knew they had a lot of ability,” Warren said. “If you don’t get the price you want, you keep on going with them.”
For as far as they’ll take you, both horses have thrived under trainer Ben Colebrook, who had to sprint from Aqueduct to JFK International Airport after Raise Cain won the Gotham to get to Turfway Park that night for Scoobie Quando.


Warren watched the Gotham from home. “I was there with my mom and dad in front of a computer,” Warren said. “I was happy to get him into the race with a live chance. He came in at 30-1 on the morning line (he’d go off at 23-1).”
Raise Cain, ridden by José Lezcano, was far back early. “I lost track of him with the mud,” Warren said. “Then I saw him coming. I said, ‘That’s Raise Cain.’ He’s moving faster than the two horses in front of him. I’m thinking, ‘We’re going to win this! We’re going to win this! We were losing our minds.” After not having a stakes winner in his first four years of racing, Warren had one. “After a long time wandering in the desert,” he laughed.

Fueled by new technology, there’s an ever-changing, brave new world of wagering domestically and internationally. North American horsemen and racetracks are doing their best to be part of it, finding innovative ways to increase handle—the lifeblood of horsemen.
$ports gambling, fixed odds and international commingled pools are already operating in North American racing. Figuring out their roles in racing’s future is a difficult exercise because of the ever-changing landscape, one which includes illegal off-shore wagering operations stealing races from tracks and returning nothing to their horsemen.
Just when it seemed like sports gambling was sweeping the nation, California voters last November rejected two propositions for sports gambling by a wide margin.
Five and a half months later, sports gambling was passed in Kentucky.
On March 22, the FanDuel Group, which includes FanDuel Sportsbook, FanDuel Racing, FanDuel TV and TVG.com and the Breeders’ Cup Limited announced a multi-year agreement to extend FanDuel’s status as the Official Wagering Partner of the Breeders’ Cup World Championships. FanDuel will continue as a title partner for both the Breeders’ Cup Juvenile and the Breeders’ Cup Mile.

“FanDuel has been a great partner for the Breeders’ Cup because horse racing is in their DNA,” Breeders’ Cup CEO and President Drew Fleming said. “FanDuel has an aggregate app which combines sports betting and horse wagering. The Breeders’ Cup believes sports wagering is racing’s biggest marketing opportunity. Our product will be on the bookshelf with leagues like the NBA, the NFL and Major League Baseball. Our product is great, and we’re looking forward to having that product before millions of new eyes. It’s a concentrated group. They like sports. And they like betting. It’s a great opportunity for us.”

Just nine days later after the Breeders’ Cup announcement, on the final day of the 2023 legislative session, Kentucky approved sports betting, becoming the 38th state to do so, according to the Louisville Courier-Journal. Sports betting in the Commonwealth will begin in late June.
“Kentucky had been an island, sports-wageringwise,” FanDuel Group Racing General Manager Andrew Moore said. “I think they have seen a lot of people driving out of their state to wager on sports.” FanDuel Group is a subsidiary of Flutter Entertainment, which also runs Betfair in England.
Pat Cummings, the executive director of the Thoroughbred Idea Foundation and founder and president of Global Racing Solutions, said, “I live in Lexington, and I will have an account for sports wagering. It’s real. It’s here. It’s growing.”
Not in California. Millions of dollars were spent in California to support two sports gambling propositions, and California voters rejected them. “Both were defeated,” Thoroughbred Owners of California President and CEO Bill Nader said. “We would relish the opportunity to have access to a secondary stream of income to help purse structure. If sports gambling does come to California, we need to be part of it.”
Nader, whose previous race career included six years at the New York Racing Association as senior vicepresident and chief operating officer and 15 years in various senior positions for the Hong Kong Jockey Club, is well aware of the problem of unlicensed off-shore wagering companies. “Anything that’s legal is fine,” Nader said. “It’s the unlicensed off-shore operations that are a real threat for the industry. It’s a serious threat. Effectively, it’s siphoning money from the industry with no return to the industry.”
Asked how wide-spread illegal off-shore wagering is, Nader said, “It’s more than you think.”
Nader said Martin Pubrick, Chairman of the Council of Anti-illegal Betting and Related Financial Crime of the Asian Racing Foundation, is one of the world’s most knowledgeable racing officials on illegal offshore operations. He said, “Illegal betting operators have an increase in customers visiting their websites that is almost twice as high a growth race as legal licensed operators. Illegal betting is a major threat to racing and sports integrity, and if not combatted, can completely undermine public confidence in racing and sports. As betting on horse racing and other sports continue to globalize, it is increasingly difficult to differentiate between online legal and illegal betting operators.”
Meanwhile, sports gambling continues to grow. According to Moore, racing handle in the United States last year was more than $11 billion, and sports betting in January 2023, was $10 billion—a number which will only grow when Kentucky adds it.
“This is an important opportunity for racing,” Moore said. “It’s very important for racing not to miss that opportunity. My fear is that if this chance is missed, sports bettors will find different things to bet than horse
racing. This is where the new audience is. This is where the next generation of bettors is. I’m really excited about getting horse racing in front of them.”
How will they respond? FanDuel started its new horse wagering/sports wagering app in December. “We’re seeing a strong takeoff,” Moore said. “We have had tens of thousands of people betting on horse racing for the first time. We’re very excited for the Kentucky Derby to come.”
Asked if there’s a risk horse racing bettors will switch to sports betting, Moore said, “They already are. That doesn’t mean they’re going to abandon horse racing. Racing as a standalone product can’t compete with sports betting. It needs to be available in that world.”

Asked the same question about losing racing bettors to sports betting, Fleming said, “Sports betting far outweighs the risk.”
Will that new audience demand a different form of wagering more in tune with their experience betting on sports? “I think that fixed odds is a huge opportunity in the United States,” Moore said. “I think it would be a game-changer. I love pari-mutuel, but pari-mutuel is dated. There are a lot of important considerations with fixed odds. Horsemen and tracks are very wary. But parimutuel is already fading out. Opportunities to innovate would be worth the risks.”

Monmouth Park has already taken that risk. The New Jersey track began offering fixed odds last August. “Five years from now, fixed odds will be 50 percent of the handle on horse racing in New Jersey,” Monmouth Park’s Chairman and CEO Dennis Drazin told John Brennan on August 4 in his online story (njonlinegambling.com), “younger people love it because they are used to a sports betting mentality. A lot of older bettors—they are more reluctant to try something new. We need something to attract a lot of new customers, and the idea of fixed odds has always appealed to me.”

It’s appealing to lots of people around the globe. At the National Horsemen’s Benevolent & Protective Association and Association of Racing Commissioners Conference March 6–10 in New Orleans, Michele Fischer, vice-president of SIS Content Services, said that $44.3 billion globally was wagered worldwide through fixed odds on horse racing last year—led by Australia ($19.1 billion) and the UK ($12.9 billion). “We’ve really had a mantra to educate our members on what’s coming,” National HBPA CEO Eric Hamelback told Jennie Rees in her story about the conference. “I believe sports wagering and fixed odds are in our future. But it’s up to us to continue to educate everyone properly on the pros, the cons and the nuances of what’s going on.”

Moore is certainly doing his part. “We have a lot of skin in the game,” Moore said. “We have a lot of long-standing partnerships. Whatever we do, we’ll be in consultation. Over the next few years, we’re going to push it hard. You can bring a lot of new customers into the sport. We all know the frustration of going to the window, placing a bet and thinking you’re getting 5-1, and getting much lower odds. Try to explain that to a new customer. When you bring someone new into racing, it’s hard to hold on to new bettors in the age of instant gratification.”
Cummings says he’s a “huge fan” of fixed odds, with a twist: “We need it. We don’t need it to replace pari-mutuel wagering. We need it to complement pari-mutuel wagering.”
Pari-mutuel wagering suffers when huge bets are sent electronically in the final seconds before post time. They skew odds and screw winning bettors with dramatically less return.
In his March 23, 2023, story in The Financial Times, Oliver Roeder wrote that computer-assisted wagers (CAWs) made by four very large bettors generate as much as one-third of the national handle for the year.
He also said that research from Cummings showed CAW handle has increased 150 percent in the past 20 years, while betting from the general public decreased 63 percent.

“The current trend is that the one or two biggest players are having a deleterious effect on mainstream players for sure,” Cummings said. “It causes higher takeout, less churn and really makes it difficult for your average player. Mandatory payout days are feeding days for the CAWs. They kill it on mandatory payout days.”
Fixed odds eliminate that problem.
Racing’s inherent nature could be a powerful inducement to sports bettors who want instant gratification. Sports bettors must suffer through two or three hours of changing scores, momentum shifts and possibly meaningless scores at the end of a game that can cost them their wager. Horse races are over in two minutes or less. And simulcasting allows bettors either on-track or off-track to switch racetracks in seconds.
Racetracks from different countries working together can keep all bettors busy. With commingled pools, odds can be more attractive. “For the Breeders’ Cup, we started with international combined pools in 1996,” Fleming said. “We are very proud we had 26 countries mingle into our common, global pool last year. Then we had seven other countries with separate parimutuel pools. To the Breeders’ Cup, we put our international participation as one of our pillars. We seek the best horses and also work with our global partners to promote the sport internationally and have strong international wagering.”
Of course, the Breeders’ Cup isn’t the only entity already working internationally. On September 22, last fall, the New York Racing Association Current Management Solutions (CMS), a subsidiary of NYRA, and 1/ST Content announced a 10-year partnership to expand distribution of North American racing internationally. Part of the agreement calls for NYRA CMS to acquire a significant equity position in TSG Global Wagering Solution, a 1/ST subsidiary company.
“This agreement assures that North American horse racing’s stakeholders are the primary beneficiaries of revenues generated through international wagering, further strengthening the domestic



industry for the next generation of fan and bettor,” according to 1/ST Content’s CEO Gregg Colvin. NYRA’s Chief Revenue Officer Tony Allevaro said, “Sports fans and bettors around the world can look forward to more coverage of top-quality racing than ever before.”
1/ST Content’s distribution network stretches to the United Kingdom, Ireland, Europe, Australia, New Zealand and Africa, as well as serving 1/ST Racing’s Gulfstream Park, Santa Anita, Golden Gate Fields, Laurel and Pimlico, NYRA’s Belmont Park, Saratoga and Aqueduct, Del Mar, Keeneland, Tampa Bay Downs and Woodbine.
On April 4, it was announced that from May 1, BetMakers’ Global Racing Network’s (GRN) race meetings will be available for inclusion in 1/ST Content’s broadcast schedule. This will result in signals from tracks such as Kentucky Downs, Charles Town, Mahoning Valley, Penn National, Sam Houston, Zia Park and Monmouth Park benefiting from increased global exposure.

BetMakers’ Chief Executive Officer Jake Henson said, “The partnership with 1/ST Content is designed to be an important addition to BetMakers’ Global Racing Network, further broadening our global racing distribution base with a strong and credible partner in expansive markets, which can deliver enhanced returns to our racetrack partners.”
Founded in 2000, Betfair has been offering international wagering for more than 20 years. With its headquarters in Hammersmith in London (England) and overseas hubs in Malta and Ceuta, Spain, Betfair offers horse racing, sports betting and online casino, poker and bingo.
In November 2009, Betfair announced a deal with the New York Racing Association to start wagering immediately on Aqueduct. TVG Network, which is now FanDuel TV, was acquired in 2009 for $50 million. In February 2016, Betfair merged with Paddy Power to create Flutter Entertainment. Two years later, Betfair offered live-betting customers fixed odds.
Another European company, XBGlobal.com, based in Germany, offers customers wagers, which are “directly commingled into host track pools, giving you access to the world’s most lucrative wagers,” and offers marquis Thoroughbred tracks in the United States, simulcasting from Chile and greyhound racing. XBGlobal.com is an affiliate of Xpressbet, LLC, on file with the Oregon Racing Commission—a site chosen because of tax advantages.
There is a worldwide racing stage, and North American tracks have yet to be involved. The World Pool offers international, commingling pools with top racing events operated through the Hong Kong Jockey Club. The first World Pool event was at Royal Ascot in 2019. Since then, it has been expanded to cover the Dubai World Cup in Meydan, the 2000 Guineas at Newmarket, The Oaks and The Derby (both run at Epsom Downs in the United Kingdom), Gold Cup Day in South Africa and Irish Champions Day at Leopardstown in Ireland.
This year, the World Pool has been expanded to include the Lightning Stakes Day in Australia, the Saudi Cup and the Irish Derby. That gives the World Pool 25 dates, up four from last year, including Melbourne Cup Day in Australia.
Asked about the World Pool, Breeders’ Cup’s Fleming said, “We have continued dialogue with Hong Kong and other jurisdictions. Hong Kong did the Breeders’ Cup last year. Anything is possible. We already operate our own global pool since 1996. We want to grow the pie.”

FanDuel’s Moore said, “It will be interesting to see how it works out.”

The same can be said for new wagering innovations in a continually changing global landscape. Racing’s future depends on it.
“We need to modernize and give our customers confidence that we can compete for the wagering dollar,” Cummings said. “We’re really not trying today. We’re existing. There are a lot of reasons to be pessimistic about horse racing, but there’s one key positive. We have not tried to grow the betting. We need to modernize and give our customers confidence that we can compete for the wagering dollar.”
The competition has never been greater.
Technology waits for no one.

800-821-4557
abacusanimalflooring.com


These very popular stocks are manufactured so that they can be moved out of the way or to another location when needed. They roll easily even over un-even ground.
Features removeable doors and bars as needed. The side rail will lower 10 inches. All the closures have stainless steel pins that are attached to the posts with stainless steel cables in their respective locations so they cannot be misplaced.
Horses will enter these stocks easily when loaded using the side rail instead of the end doors.



Options: Mid Bar and Dental Bar available as well as custom designs.
FPD is considered a leader in bringing groundbreaking products and service to the farrier industry as a wholesale distributor of farrier and equine products.



ProspectiveFoal,StallionInfertility”
of Hammer,Claiming, Liability, Farm Packages”
F I N D A N F P D D E A L E R N E A R Y O U farrierproducts com/locations • (800) 468-2879
farrierproducts com/fieldguide facebook com/FarrierProductDistribution youtube com/farrierproducts • instagram com/fpdinc
Contact: Anya Sheckley 189 JohnnyCakeHollowRd. Pine Plains,New York 12567 Tel: 646-872-6843 Fax: 518-398-5143
Email: info@hammertowninsurance.com

FL 34482
Website: www.niallbrennan.com
Telephone: Office 352 732-7459 or Training Centre 352 629 3994 Email: nbstables@aol.com
Facilities:
■ 3/4 mile dirt track
■ 3/4 mile rolling turf course
■ Aquaciser
■ 4stall starting gate

■ European Walkers
ADVERTISE HERE AND BE PART OF OUR NEXT ISSUE!




CALL CALL US BY FRIDAY, JULY 7, 2023
Services Offered: Breaking, Sales Prep R&R, Layups, etc..
Address:
Don't StartWithout Us!
Don't StartWithout Us!
Don't StartWithout Us!
Custom-made racetrack& traininggates
Custom-made racetrack& traininggates
Custom-made racetrack& traininggates








Builtfor strength anddurability
Builtfor strength anddurability
Builtfor strength anddurability
50+ yearsinthe industry
50+ yearsinthe industry
50+ yearsinthe industry
Contact:
Contact:
Contact:
T: DianeFleming(602) 524-8437
T: DianeFleming(602) 524-8437
T: DianeFleming(602) 524-8437
Dave Russ (602) 418-1735
Dave Russ (602) 418-1735
Dave Russ (602) 418-1735
www.truecentergate.com
www.truecentergate.com
Claiming, Surgical/Medical,Liability,Farm
“EquineMortality,
“Fall












































How closely do you follow your veterinarian’s advice if it conflicts with your gut feeling about your horse?



Well, if it conflicts with my gut feeling, percentage wise, I would say 65 percent I’d follow the vet. It all depends on the situation. Is it one I’ve dealt with in the past? If so, I would use my experience, especially if it’s a younger vet, one fresh out of school. If I’m totally confident in my vet, I listen to him.

I don’t ask a veterinarian for advice. I have a license. They have a license.
You talk to him. Common sense prevails.


I stick with my gut feeling, but I do trust my vets because I can’t see an X-ray. I can’t see an ultrasound. I’m pretty opinionated. These horses will talk to you if you listen.
That’s a good question. You always want to do what’s best for the horse. You kind of have to go along with the veterinarian These days, with just being way more cautious—not that it was irrelevant before—if you have a gut feeling that a horse is fine, you still do diagnostics to make sure your horse is fine.

A lot of times, I would use the vet for a sounding board. I’d really consider his opinion. Ninety-nine percent of the time we come to a consensus.

I probably use a vet’s recommendation, maybe 85 percent of the time. I have gone against their recommendation because of my gut. Usually, my gut is the right answer. For sure, there are times when my gut is wrong. But sometimes the scientific answer is not always correct. Generally, the advice given from the vet is the textbook version, and not everything is textbook in horse racing.
That’s a good question. I usually have a good enough relationship with my vets. I really trust their judgment. It seems like nowadays there aren’t many vets who would do something you don’t want, something that you really don’t need, whatever it takes to get a horse in a race. That’s not in our game anymore. I have in my head what I think, but usually it matches well with my vets.